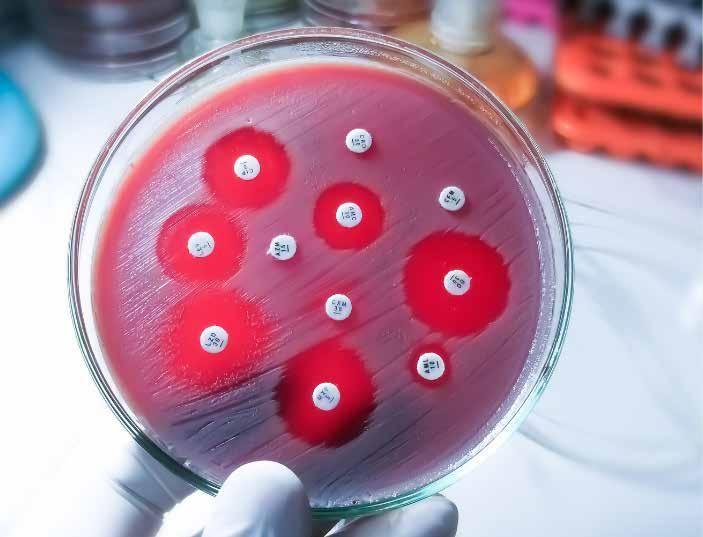
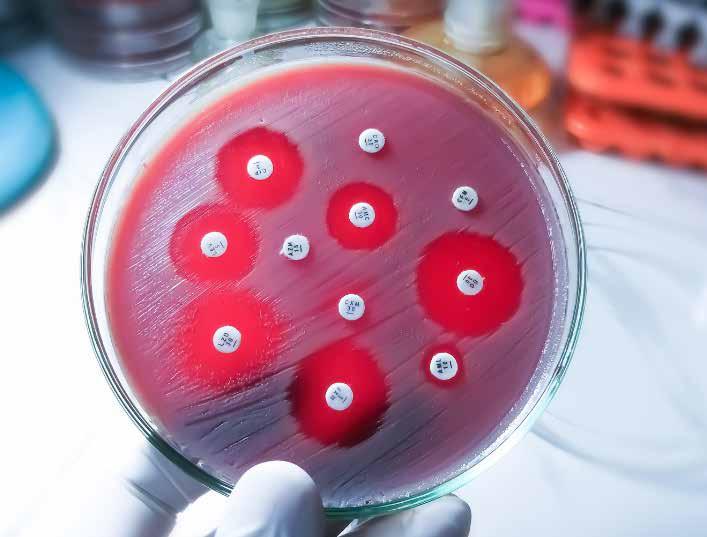

![]()














Dear Friends
This year, the Hebrew University celebrates the 100th year since the opening of its first campus on Mount Scopus in 1925 by none other than Lord Balfour himself. The history of the Hebrew University however goes way back to 1897 when at the First Zionist Congress, Zvi Herman Shapira (the father of the JNF) put forward the idea of a University of the Jewish People that would also promote Hebrew – the treasured language of the Jewish People. The idea bore fruit and in 1918, the cornerstone for the first campus on Mount Scopus was laid in the presence of many dignitaries.
I doubt whether any other Jewish institution can lay claim to the illustrious founders of the Hebrew University – Albert Einstein, Chaim Weizmann, Sigmund Freud, Chaim Nachman Bialik and Martin Buber and in fact Albert Einstein gave the first lecture at the Hebrew University in 1923.
Today, the University boasts six campuses – three in Jerusalem plus Rehovot, Beit Dagan and Eilat with some 25,000 students, 1,050 faculty members, an active arm to promote commercialisation of the many patents that originate through researchers at the Hebrew University and so much more.
Like for Jews all over the world, the last 18 months have been heartbreaking as we have all hoped and prayed for the release of all the hostages held by Hamas and at the time of writing this report, there remain some 60 hostages still in Hamas’s hands. During these
challenging months, whilst diaspora Jews have risen to the occasion and done wonders in terms of supporting Israel, the Hebrew University has done its utmost to support students, faculty members and the greater population of Israel. For the hostages, you will read later in our Yearbook that the Hebrew University is offering free tuition for them and their children.
We are delighted to be celebrating our centenary with a bumper version of our Yearbook in both an electronic version and for those that still like to ‘hold a copy in their hands’ we have a limited number of hard copies available from our office.
In the spirit of Israel’s amazing resilience and fortitude, our Yearbook features some of the remarkable work and activities that took place both in Israel and here in Australia. Despite the challenges, the Hebrew University continues to be “a shining light unto the nations” and we, as the Australian Friends, are proud to represent Israel’s and indeed one of the world’s premier institutions of higher learning here in Australia.
This Yearbook would not be possible without the loyal and dedicated small team who ensure that the Australian Friends presence is felt throughout Australia. This small team consists of Linda Kugel, Danielle Salomon and Gina Malka who not only manage our Sydney/National office but also support our parttime representatives in Melbourne, Yifat Biran and in Perth, Lauren Ross.
I also wish to thank Shira Halberstadt for the design of our Yearbook and to Philip Joel of Kwik Kopy who always goes the extra mile for us.
We could not produce this Yearbook without the support of our advertisers many of whom have advertised with us for more than 20 years so a very big thank you for your continued support.
Finally, to our members, donors and supporters throughout Australia, we are most appreciative of your friendship and donations to medical research through Hebrew U Health Promotions or for student support for Australian students wishing to study at the Hebrew University through our scholarship fund both of which entities offer Australian donors tax deductibility.
We hope you will enjoy our 2025 Yearbook and that with your support, we will ensure that the Hebrew University continues as Israel’s pre-eminent university for generations to come.
Thank you for your continuing support and friendship.

ROBERT SCHNEIDER Chief Executive Officer
Australian Governors of the Hebrew University of Jerusalem
Mr Michael Dunkel Governor
Mr Robert Simons OAM Governor
Mr Sam Lipski AM Governor
Mr Jerremy Leibler Governor
Mr Barry Joseph Governor
Mr Philip Moses Governor
Australian Recipients of Honorary Doctorates of the Hebrew University of Jerusalem
Mr Michael Dunkel (NSW)
Mrs Agnes Ginges (NSW)
Mr John Howard AC (NSW)
Professor Leon Mann AO (VIC)
Mr Stuart Silbert OAM (WA)
Mr Robert Simons OAM (NSW)
Mr Harry Triguboff AO (NSW)
Mr Marc Besen AO (VIC)
Mr Israel Blankfield * (VIC)
Mr Ron Castan AM QC * (VIC)
Sir Zelman Cowen AK * (VIC)
Mr Berel Ginges * (NSW)
Mr John Hammond * (NSW)
Mr Robert J Hawke AC * (VIC)
Mr Harry Hoffman AM * (WA)
Dr Henry Krongold AM * (VIC)
Mr Isador Magid AM * (VIC)
Mr Richard Pratt * (VIC)
* (Deceased)
Assoc Prof Peter Winterton AM Governor
Mr Mark Besen AC Honorary Governor
Mrs Agnes Ginges Honorary Governor
Professor Leon Mann AO Honorary Governor
Mr Stuart Silbert OAM Honorary Governor
Mr Harry Triguboff AO Honorary Governor
Australian Recipients of Honorary Fellowships of the Hebrew University of Jerusalem
Mr Michael Dunkel (NSW)
Mrs Shirley Ehrlich (NSW)
Mrs Sylvia Hoffman AM (WA)
Mr Leon Kempler OAM (VIC)
Mr Barry Joseph (NSW)
Professor Leon Mann AO (VIC)
Mr Robert McGarvie AC QC (VIC)
Mr Philip Moses (NSW)
Mr Stuart Silbert OAM (WA)
Mr Robert Simons OAM (NSW)
Mrs Basil Starr (VIC)
Mr Israel Blankfield * (VIC)
Mr Ron Castan AM QC * (VIC)
Mr Alroy Cohen * (NSW)
Mr Maurice Cohen OBE * (VIC)
Mrs Felicia Einhorn * (NSW)
Mr Stefan Einhorn OAM * (NSW)
Mr Joseph Frank * (NSW)
Mr Max Freilich OBE * (NSW)
Mr Berel Ginges * (NSW)
Mrs Nerida Goodman MBE * (NSW)
Mr John Hammond * (NSW)
Mr Robert J Hawke AC * (VIC)
Mr A D Hallam * (VIC)
Mr Harry Hoffman AM * (WA)
Dr Jack Hoffman OAM * (WA)
Mr Alan K Milston OAM * (NSW)
Mr Wolfie Pizem OAM * (NSW)
Professor Louis Waller AO * (VIC)
Australian Friends of the Hebrew University of Jerusalem
President: Mr Michael Dunkel
Vice President: Mr Philip Moses
Hon. Treasurer Ms Laura Dunkel
Hon. Secretary Mr Barry Joseph
NSW State President: Mr Phillip Joel
WA State President: Ass. Prof. Peter Winterton AM
Hon. Chairman: Mr Robert Simons OAM
Chief Executive: Mr Robert Schneider
National Office
P O Box 876
Bondi Junction NSW 1355
Tel.: (02) 9389 2825
Fax: 02 9387 5584
Email: austfhu@austfhu.org.au
Website: www.austfhu.org.au
The Hebrew University of Jerusalem, Israel’s first university, is a multidisciplinary institution of higher learning and research where intellectual pioneering, cutting-edge discovery, and a passion for learning flourish. It is a center of international repute, with ties extending to the worldwide scientific and academic community, where teaching and research drive innovation and provide the broadest of education for its students.
Ranked among the world’s leading universities, the Hebrew University is an institution where excellence is emphasized; where advanced, postgraduate study and research are encouraged; and where special programs and conferences attract students and academics from around the world. At its core, the Hebrew University’s mission is to develop cutting- edge research, to educate future leaders, and to nurture generations of outstanding scientists and scholars in all fields of learning.
President
Prof. Asher Cohen
Rector
Prof. Tamir Sheafer
Chairman of the Board of Governors
Daniel Schlessinger
Chancellor
Prof. Menahem Ben-Sasson
Honorary Chairs of the Board of Governors
Michael Federmann Charles H. Goodman
Vice-President for Advancement & External Relations
Ambassador Yossi Gal
Vice-President for Research & Development
Prof. Aharon Palmon
Vice-President & Director-General
Yishai Fraenkel
Vice-President for International Affairs
Prof. Oron Shagrir
Vice-President for Strategy & Diversity
Prof. Mona Khoury
Vice-Rectors
Prof. Lilach Sagiv, Prof. Avi-Chai Hovav
Comptroller
Zvi Aizenstein
Director, Division for Advancement & External Relations
Ram Semo
6 campuses: three in Jerusalem (Mount Scopus, Edmond J. Safra, and Ein Kerem) and in Rehovot, Beit Dagan, and Eilat
4,242 projects in progress in University departments and some 100 subject - related and interdisciplinary research centers
25,000+ students , including 13,242 undergraduates, 6,435 master’s students, 2,193 doctoral candidates, and 2,741 overseas, pre-academic students, postdoctoral fellows, and others
1,034 faculty members




Michael Dunkel
(Note this Report relates to the year- end 30 June 2024)
Whilst the lifting of Covid restrictions and the resumption of international travel allowed us to resume our activities on a more normal basis, the events of October 7 and the subsequent war in Israel is once again restricting our ability to receive visitors from overseas and to send students to the University. In addition, this has meant we will not plan for another Legacy Mission until 2025.
The 2024 Board of Governors Meeting was held from June 1 to 4. Unfortunately, due to the University’s decision to continue with the shortened format, Australian Governors decided it was not worthwhile making the long journey to attend. However, Rob Schneider, our CEO and I did attend. The highlight of the Meeting was a visit to the Nova Festival site which was a very emotional experience. At the Meeting, two Australians were recognised. A plaque was placed on the Wall of Life in honour of the late Jack Gubbay whilst longtime supporter Stuart Silbert OAM was elevated to Honorary Governor. For the Meeting in 2025, where the centenary of the opening of the University will be celebrated, the University will revert to its original format. We plan to ensure that the Australian Friends will be well represented at the event.
As arrangements had been made prior to October 7 2023, we were able to proceed with one speaker from the University, the Alpha Program graduate, Niv Gronovich. Niv spoke in Sydney and Melbourne at synagogues and schools and was very well received by the young people and students. In September 2024, we were fortunate in that Professor Gila Kahila Bar-Gal was in Sydney on sabbatical. Gila spoke a number of times in Sydney, Melbourne and Perth
The Golimdja William Cooper Memorial Scholarship (GWCMS) was launched in Melbourne on November 19 and in Sydney on December 4. This scholarship covers costs of an Indigenous Australian for post graduate study at the Hebrew University in one of the following programs:
• The Global International Development Studies Program,
• International MSc Program in Agricultural Sciences,
• The International Master of Public Health Program,
• The International MSc Program in Biomedical Sciences in the Faculty of Dental Medicine.
Applications are now open for the Scholarship.
The researchers funded by the Zelman Cowen Academic Initiatives in the Australian universities and in the Hebrew University have now commenced their second year of research and have produced some excellent results. Some of the projects may continue in the future under different funding. With the prospect of students and academic researchers being able to travel again between Australia and Israel the grants can once more be awarded. This will enable the resumption of these important research and exchange programs of both students and faculty members.
Our efforts to develop further cooperation between the Hebrew University and Australian universities have been hampered by the events of October 7. This has also meant that the scholarships normally awarded on an annual basis to Australian students at the Australian Catholic University studying archeology, enabling them to participate in digs conducted by the Hebrew University Faculty of Archeology have been put on hold.
Whilst the re-establishment of the Victorian Division of the Friends is not yet completed, the Steering Committee, which was formed last
year, has held a number of successful functions throughout the year. The Western Australian Friends have continued, their activities and have received visitors from interstate and overseas holding a number of successful speaker functions.
None of our work would be possible without the dedication and commitment of our staff. Particularly, I wish to thank our CEO, Robert Schneider, for his enthusiasm and determination to overcome the challenges faced following the events of October 7. His efforts to not only manage day to day issues, but also continue with the goal of increasing awareness of the University and of communicating with donors, can only be described as exceptional. I also thank Linda Kugel, our office administrator, and other members of staff for their dedication and hard work.
Finally, I thank my Executive and Committee for their efforts and support and in particular, I want to acknowledge the exceptional contribution of our treasurer, Robert Greenfield who is stepping down from this role at the AGM. Robert will remain a director and committee member and we are grateful for his continued involvement.






(Note this Report relates to the year- end 30 June 2024)
I want to express my sincere gratitude to our dedicated board members for their continued support throughout my year as NSW President.
This last financial year has been marked by several exciting initiatives, including youth events during Niv Gronovich’s visit to Australia last November.
Considering the uncertain situation in the Middle East, it was decided to postpone any promotion of the Legacy Mission until the situation becomes clearer.
The Honours Club continues to attract regular supporters with some new faces attending from time-to-time. I believe that once we have our old venue back at the Waverley Library, attendance will improve.
It was decided to delay the Goilimdja William Cooper Memorial Scholarship until
the situation in Israel stabilizes.
In August and September this year, we had several engaging events featuring visiting Hebrew University Professor Gila Kahila Bar-Gal. Her expertise in DNA analysis from archaeological samples and wildlife forensics contributed greatly to helping identify human remains after the October 7 massacre.
I would also like to commend and applaud Mr. Rob Schneider, our CEO, for his tireless efforts in ensuring the smooth operation of our institution with the able support of Linda Kugel, Student Liaison Officer Yael Adar and now also with the hiring of Danielle Salomon to enhance our marketing efforts.
As we look ahead, we anticipate new and uncertain challenges, but with Mr. Schneider’s leadership and his new team, we are well-prepared to tackle the year ahead.



(Note this Report relates to the year- end 30 June 2024)
Since my report of only one year ago the world has changed forever. Israel and the Jewish peoples came under horrific, barbaric attack on the 7th October 2023, when Hamas terrorists invaded Israel, took 240 hostages and murdered some 1200 people in ways that were reminiscent of the Middle Ages and the Pogroms of the nineteenth century in what was then the Russian empire.
Israel, as would be expected responded with unequivocal force against Hamas. The horrors of war, became very evident to all, every day as the regular media, and social media in particular sent images around the world from the conflict zone. Individuals, some driven by hate of Israel, and others by hate of Jews and yet others shocked by the realities of a war zone in an urban landscape united in their voice about the conflict, resulting in a ferocious rise of antisemitism around the world. For the first time in a generation many Australian Jews have felt physically and emotionally unsafe. For older Jewish Australians, some of whom had heard of nothing else but antisemitism since their childhood, the emotional trauma has been almost unbearable. A particular hot bed for this movement has been university campuses, where overt antisemitic demonstrations have taken place and other universities where the antisemitic voice has
been less overt, but none the less toxic. The result of this has been fear in the hearts of many young Jewish Australians to attend university, increasing the importance for them to be able to study and learn at the Hebrew University of Jerusalem and other institutions in Israel.
Clearly the world has a problem in seeing a militarily strong Jewish people. The world at large is used to see Jews being herded into concentration camps on grainy black and white archival footage and of Jews being confined either actively or passively in ghettos. The Jewish people changed forever with the foundation of Israel, not only could jews be clever, but also be militarily strong. This strength, has its foundations in institutions such as the Hebrew University of Jerusalem, which in 2025 will be celebrating the centenary of its doors opening to students.
The above overview sets the scene to demonstrate why social functions and events have been thin on the ground this year.
The highlight of the year was the visit early in September 2024 of the world-renowned scientist, Prof Gila Kahila Bar-Gal, who had planned to be in Australia for a year’s sabbatical, but because of the political
climate in Australia will be curtailing her visit. Professor Kahila Bar-Gal is the Head of the Molecular Evolution Laboratory at the Hebrew University as well as the Director of the National Natural History Collection. Her depth of knowledge and range of publication is indeed breathtaking. More than 100 people gathered in the Sylvia & Harry Hoffman Hall at Carmel School to listen to her in conversation with well-known media personality, Caroline Di Russo. During her three-day visit to Perth, she addressed Carmel School students, ‘Living in Retirement’, held a joint function with the AICC and was guest at luncheon to raise funds to facilitate students to be able to travel to Israel.
As we look to 2025 may there be changes for the better.
Fundraising in 2024 has been problematic at best. In Perth there are a number of factors making this especially difficult. Last year I reported on the impediments to fund raising, sadly these have not resolved, but are worse than they were.
The construction of the new J Hub has taken considerable physical, financial and human resources. It opened earlier this year and will make a significant contribution to Jewish life in Western Australia, but is still in need of further funds.
The current economic climate, political uncertainties, the Ukraine war and the current war in the Middle East, where the state of Israel is fighting for its very existence whilst the rest of the world argues about how to appease terror.
Rising interest rates in Australia have placed many Australians under financial pressure, whilst this has had a minimal effect on major donors; the increasing use by the next generation of the Bank of Mum and Dad, has reduced the ability of older members of the community to be as benevolent as they may have wanted to be.
The relevance of “far away HUJ” to the WA community. Other Jewish charities have saturated the space, which makes it harder for HUJ to be seen to be relevant. Scholarships are tangible to the local community, and we are making ground on this space. The current situation on Australian university campuses has highlighted this need.
Peter Winterton as President and the five other committee members; Yael Jacobsen, Lynne Swersky, Ken Bud, Martin Brezger, and Hilary Winterton have made 2024 a year to remember. Their enlightened counsel and the input from Dr Raphaely has made for many a lively meeting and for this I thank them. Hilary Winterton’s efforts to ensure that no one goes home hungry does much to enhance meetings.
Robert Schneider and his dedicated team, keep the front door of the organization open. Robert’s attention to detail and governance issues is essential for this organization to run responsibly and instil confidence within our community, allowing members to feel secure in making bequests and ongoing donations. He has stepped in, when needed to help in The West, through supporting the team in Perth.
I would like to thank him.
WISHING THE AUSTRALIAN FRIENDS OF THE HEBREW UNIVERSITY CONTINUED SUCCESS
Naomi & Jesse Tracton, Michelle & Avi Ben David and Ian Tracton

(Note this Report relates to the year- end 30 June 2024)
I am proud to be part of an organisation that held its first AGM 77 years ago, in fact the NSW branch held its first AGM 87 years ago!
Our longevity is surely a community record, and we owe a debt of gratitude to those who had the foresight to set up an organisation in Australia to support the Hebrew University and to those whose commitment and ongoing support allow us to continue with our mandate of supporting the Hebrew University in Australia.
Unfortunately, the last year has been marred by the war in Israel and the fact that Australian universities have abided by the DFAT warning insofar as travel to Israel is concerned.
In addition, we have seen extensive proPalestinian or rather anti-Israel activity on many university campuses that has affected our ability to attract Australian students. Such activity has also made visits by Israeli academics intolerable.
Our fundraising efforts have also been affected by the war since we are not seen as an “emergency need” organisation but we are grateful to existing and new donors who recognise the Hebrew University’s pivotal role in higher education in Israel
and continue to support our efforts through donations, advertising and membership.
I express my gratitude to Michael Dunkel, our Federal President for his ongoing support, wise counsel and stewardship of the organisation. Michael Dunkel also plays an international role as a member of the Executive Committee of the Hebrew University.
I am grateful for the support of all board members but in particular wish to thank our Treasurer, Robert Greenfield who has been a tremendous resource not just to the Friends, but also to me personally. Robert has decided to step down from this role at this year’s AGM but we are delighted that he will remain a director and board member.
Vice President Philip Moses is our organisational memory and the man we all turn to for information regarding the past. Thank you, Philip.
I am grateful to NSW President Phillip Joel who is from a younger generation and brings much needed insights into a younger demographic that we need to embrace going forward. Phillip is also a very generous
contributor to the Australian Friends not least by undertaking our printing needs often at no cost or if charged for, at rates well below those of other commercial printing outfits.
I am also grateful to WA President Peter Winterton for his ongoing stewardship of our WA committee and for his generous support and hospitality particularly during visits to Perth by Hebrew University guests.
Barry Joseph, our Honorary Secretary is of great assistance in assessing Australian students applying for financial assistance to study at the Hebrew University and often participates in the interview process.
The office in Sydney serves as both the Head Office and NSW office of the Australian Friends and provides resources and services nationally.
Committee meetings are held every second month and where necessary, a Federal meeting is convened on the same date as a NSW committee meeting.
WA holds regular committee meetings and where necessary, a meeting is held with our Vic. steering committee via zoom.
Weekly zoom meetings are held with our part-time professionals in Vic. and WA – Dr Yif’at Biran and Dr Talia Raphaely respectively. These zoom meetings include me and our professional staff in the National Office.
A few months ago, our board requested that we undergo a cybersecurity audit by an independent firm with expertise in this area. The audit was conducted by Risk2Solution
and I am pleased to say that by-and-large, they were comfortable that our data and work processes are run on a secure basis.
I am pleased to report that for the first time since Covid, we have a wonderful team of professionals serving our organisation. All these professionals serve on a part-time basis as we are not large enough to warrant a fulltime team, but the current arrangement works very well, and I am grateful for the dedication of my team even on days when they are not in the office.
Linda Kugel has continued as our most efficient and enthusiastic office manager and her commitment and dedication is something that I value very much indeed. It is a pleasure to have Linda on board.
The role of Student Liaison Officer is now ably filled on a part-time basis by Yael Adar and earlier this year, we took a decision to uplift our marketing by employing a part-time Marketing Manager. This role is filled by Danielle Salomon who brings a wealth of experience and talent and in the short time that she has been with us, our marketing outreach and ability to connect to a broader audience has improved considerably.
In January, our board also took a decision to transfer the bookkeeping function to a professional accounting firm and I am grateful to outgoing treasurer, Robert Greenfield for his role in implementing this arrangement which is working very well.
Joe Gelbart, a retired engineer with much

experience in data processing continues to assist us a day or two per week as needed.
As I mentioned in my last year’s report, we have retained the services of two dynamic part timers – Yif’at Biran in Melbourne and Talia Raphaely in Perth. The impact of both these ladies has already boosted our presence in these cities and their assistance in organising programs locally for our supporters and visitors from Israel is of great benefit.
Our lease runs until December 2025.There is much development in Bondi Junction, and we are aware of a development proposal for an apartment block to built on our office site so we will need to consider the possibility of alternative premises if we are not advised well in advance that we will be offered a new lease.
As mentioned in my previous Annual Report, our ThankQ data base system enables us to manage both personal and financial data on the same system.
Our data base consultant updates entries during his weekly visits to the office and Linda and Danielle are also familiar with ThankQ and are able to serve as a back-up as needed.
We continue to reach out to Australian students encouraging them to embark on both shortterm and long-term studies at the Hebrew University. Unfortunately, this has been
virtually impossible following the October 7 massacre and the DFAT travel warning for Israel. This situation has been exacerbated by the fact that so long as the DFAT warning is in place, Australian universities are not granting permission to Australian students to study in Israel and earn credits.
Marketing: We continue to promote the excellence of the Hebrew University as well as student programs on a regular basis.
With the appointment of a marketing manager, our website has been revamped and our marketing and promotional output enhanced. Our social media now runs on a schedule, and news articles are posted regularly in addition to flyers for online courses.
Despite the constraints referred to above, we have been able to assist three students who have been determined to study at the Hebrew University, two of them being non-Jewish.
We are also hoping that the ACU Ancient Israel program and archaeological dig run in partnership with the Hebrew University will resume in 2025 – it was unfortunately cancelled in 2024.
On a more positive note, in July 2023, the Kelly+Partners Scholarship Foundation group visited Israel and attended a morning seminar at the Hebrew University. The Australian Friends contributed towards the workshop facilitator’s fee and the feedback we have received from the group’s coordinator was very positive and we look forward to hopefully

repeating this exercise with future groups of Kelly+Partners Scholarship Foundation scholars.
At our behest, the Hebrew University for the first time held a Digital Open Day on Tuesday 16 April specifically for the Australian market as their international open days do not work for our time zone.
The event was advertised will print ads and advertorial in the Jewish News as well as paid social media advertising on Facebook and Instagram. Emails were sent to our database and directly to relevant communal organisations, schools, shuls and university contacts to be forwarded on to their networks.
Over 70 registered and in the end, we had 25 participants (excluding a few protesters who have been reported). We were all very pleased with this new initiative which we aim to repeat at an opportune time.
Golimdja William Cooper Memorial Scholarship
Unfortunately, despite the hype with the launch of this Scholarship and the securing of a donor, due to the current situation, it was decided to suspend promoting this Scholarship until the situation in Israel stabilises.
The NSW Honours Club is a great initiative for some of our mainly senior supporters who meet on the last Wednesday of every month to enjoy a presentation by a topical speaker.
Thanks to the generosity and hospitality of the Mizrachi Synagogue in North Bondi, we have held Honours Club meetings there for the last number of months. Unfortunately, parking in this area is dreadful and many of our attendees have expressed their concern about this situation. I am happy to say that it seems that
we will have our old venue in the Waverley Library Theatrette available to us from January 2025.
Once again, due to the situation in Israel, we have had to suspend promotion of the Legacy Mission until the situation stabilises.
In order to ensure sufficient numbers and cost benefits, the intention is to run the next Legacy Mission in partnership with the British Friends and we are very much hoping that with 2025 being the centenary year of the opening of the Hebrew University’s first campus on Mount Scopus in 1925, that we will be able to run a Legacy Mission in this auspicious year.
National & NSW: A USD amount equivalent to some AUD4,450,379 was received directly by the Hebrew University from an Australian connected entity. Such funds are credited as donations from Australia.
A Melbourne donor continues their substantial support for the Hebrew University’s Revivim Program and in March this year donated a further USD $327,000 towards this program. Revivim is designed to attract Israel’s best and brightest students to a career in teaching Jewish Studies in Israel’s secular middle and high schools.
An amount equating to approximately $492,000 was also donated directly by an entity with Australian connections direct to the Hebrew University for specific projects.
We had planned for a young student, Niv Gronovich from the Hebrew University’s Alpha Program for gifted students to visit Australia late October 2023. Following the tragedy of 7 October, it was unclear whether Niv would
still be able to come but the IDF granted him a special dispensation and whilst he missed the Perth leg of the visit, a highly intensive and successful program was arranged for Niv in Sydney and in Melbourne.
A successful launch of the Golimdja William Cooper Memorial Scholarship was held at the Sydney Jewish Museum in December 2023.
Victoria: Yifa’t Biran, our part-time Victorian Coordinator is a great asset and our presence in Melbourne has been boosted through her initiative and activities.
Niv Gronovich, our visiting student and I undertook an extensive program in Melbourne including visits to schools, universities, young leadership events as well as meetings with donors and supporters.
I would like to acknowledge the amazing input and support received in Melbourne from one of our Life Governors, Professor Leon Mann AO and indeed also from his wife, Leah Mann AM. Leon is indefatigable, and his energy and enthusiasm knows no bounds.
I am also grateful for the support from Jeremy Leibler, a senior partner at ABL and President of the Zionist Federation of Australia who was appointed a Governor of the Hebrew University in 2020 and reappointed in 2024.
We have a small steering committee in Melbourne who I meet with on my visits and this committee is also given the opportunity to meet with visitors from Israel. Where necessary, zoom meetings are also held.
A successful launch of the Golimdja William Cooper Memorial Scholarship was held at the Australian Jewish Museum in November 2023.
Western Australia: We have a WA committee based in Perth chaired by Assoc. Professor
Peter Winterton AM.
This committee meets on a regular basis and is supported by a part- time PR Officer, Talia Raphaely.
Articles about the Australian Friends and the Hebrew University are featured regularly in the local weekly, The Maccabean.
A number of public events are also held in Perth under the auspices of the local Friends committee.
Unfortunately, visiting Hebrew University student Niv Gronovich was unable to visit Perth due to the late approval for his Australian visit provided by the IDF.
An extensive program had been arranged for Niv by Talia who unfortunately took ill a few weeks before Niv’s proposed arrival.
In the circumstances, together with Peter and his wife, Hilary I took over the program and addressed a lunch of Perth donors generously hosted by Peter.
I also met with a number of our supporters on an individual basis.
Queensland: Articles about the Australian Friends and the Hebrew University are featured from time-to-time in the local monthly, SHALOM and the support of the SHALOM editor, David Jacobs is much appreciated.
ACT: Last November, I travelled to Canberra to attend the ACU Federal Parliamentary Interfaith Breakfast.
We enjoy a most cordial relationship with the ACU and collaborate with them on the Ancient Israel Program run jointly by the ACU and the Hebrew University.
I used the visit to also meet with the ACT rabbi as well as with ACT Jewish Community leaders.
We have been very selective in our advertising and have chosen to be part of carefully targeted Australian Jewish News editions and supplements nationally (Melbourne and Sydney editions) e.g. Yom Ha’atzmaut, Education, National Calendar.
We also advertise and run articles in the Melbourne and Sydney editions of the Jewish Report which is distributed free of charge in Sydney and in Melbourne.
The Australian Friends Yearbook – in hard copy and electronic versions – is well received by our supporters. The latest yearbook reflects the efforts of Linda Kugel in securing additional advertisers and of the impact of Danielle Salomon in giving it a more modern and userfriendly look.
E-newsletters, generally coinciding with the main Jewish holidays sharing the latest news from the Hebrew University and our own local news with our supporters.
Special greetings to mark an important event.
The 87th Board of Governors Meeting took place in Jerusalem between the Saturday 1 and Tuesday 4 June 2024. Unfortunately, the condensed format meant that some of the familiar events including the Friday night
dinner never took place. The Meeting was rather subdued in the light of the events of 7 October and participation was down on previous years.
The Board of Governors opened on the Saturday night at the stunning new location of the National Library in Jerusalem. A poignant exhibit in solidarity with the hostages, featuring empty chairs behind a glass wall, symbolised their absence and the inability to reach them. On each chair, including a baby chair and a toddler chair belonging to the Bibas family, was placed a book that matched the preferences and interests of the hostage. We then entered the reading rooms and descended the sculpted staircase to other reading halls, including the rare books room, and watched the fascinating work of the robots in the warehouse, which stores over four million books in optimum climatic conditions.
The next day we travelled by coach to the Gaza region to express solidarity with the people of the western Negev. Following the tragic events of October 7 the University has committed itself to the recovery and welfare of these communities. As Israel’s leading research institution, the University remains committed to advancing science and making meaningful societal contributions, particularly in the development of the country’s peripheral regions.
At the opening session we learned about the University’s various efforts to foster connections with the surrounding communities. Highlighting its commitment to advancing research and academia in peripheral regions, in a shared

declaration with Ofakim Mayor Itzik Danino, the University unveiled a proposal to establish a branch of the Robert H. Smith Faculty of Agriculture, Food and Environment in Ofakim.
We then visited the innovative Regavim Agricultural School, where they explored both the School’s projects and the City’s Science Centre, integral to ongoing collaborations with the Faculty of Agriculture. The visit underscored Ofakim’s vision to become Israel’s agrotech hub, with presentations highlighting this ambition.
At the Nova site near Kibbutz Re’im, where the horrific massacre claimed the lives of more than 300 attendees, we heard the story of a survivor and toured the memorial site dedicated to the victims.
In Kibbutz Alumim, we listened to Esther Marcus who recounted the heroic tales of the emergency response team members who defended the kibbutz, some of whom tragically lost their lives.
During the Board of Governors, a ceremony was held at the Wall of Life honouring the generous bequest of a donor from Perth.
Faculty members of the Hebrew University visiting Australia are always warmly welcomed and we were delighted that Professor Uzzi Rebhun, (Shlomo Argov Chair in IsraelDiaspora Relations; The A. Harman Research Institute of Contemporary Jewry; Vice Dean for International Affairs -Faculty of Humanities) visited Sydney early October 2023 under the auspices of Mandelbaum House. During this
visit, a number of events were arranged but unfortunately, due to the situation in Israel, Uzi returned home prematurely. It was a great pity that Uzi’s visit had to be cut short as there were still some valuable engagements on his itinerary including a symposium of Jewish educators at Moriah.
I was able to join Uzi at his presentation at the Sydney Jewish Museum on Wednesday 04 October and then at the Great Synagogue on Saturday 7 October – the fateful day when the southern communities were attacked, murdered and kidnapped.
I would also like to thank the staff at the Hebrew University for their ongoing assistance and support in particular those with whom I work with on a regular basis who include Amb. Yossi Gal, Vice President for Advancement & External Relations, Ram Semo, Director of Advancement & External Relations, Faith Segal, Head of the Australian Desk who is retiring at the end of 2024, Brenda Needle-Shimoni, Director of Donor Services, Rivkie Harel, Shoshana Israel, Devora Liss, Sarit Petersen, Jane Turner, Naama Oryan and Anat Yaffe.
I am also grateful for the assistance and support from my colleagues of the American Friends, the British Friends and the Canadian Friends who are always willing to share their resources with us in Australia.
Last, but certainly not least, my thanks to our members, donors, and advertisers without whose support, we would not be able to succeed in our role of continued support for the Hebrew University.

This past year has been one of outstanding recognition for the Hebrew University of Jerusalem, marked by prestigious awards, groundbreaking achievements, and remarkable contributions across science, academia, public service, and the arts.
At the 87th session of the Board of Trustees, held on June 4, 2025, the university conferred honorary doctorates on five distinguished individuals:
• Prof. Dr. Michael N. Hall, renowned molecular biologist from the University of Basel, was honoured for his groundbreaking research on cellular growth and for strengthening academic ties with Israel.
• Viviana Goren Kasam, celebrated Italian journalist and community leader, was recognised for her support of Hebrew University and her advocacy for women in science.
• Judge Esther Hayut, former President of Israel’s Supreme Court, was awarded for her influential leadership in constitutional law and judicial transparency.
• John A. Paulson, American philanthropist, was commended for his generous support of education and the arts, including major projects at the Hebrew University.
• Lea Koenig Stolper, legendary Israeli actress, was celebrated for her cultural contributions and lifelong dedication to Yiddish theatre.
In addition, the Bublick Award recognising service to the advancement of Israel—was presented to:
• Prof. Dina Ben Yehuda, a leading figure in hematology and public health policy, for her pioneering leadership in computational medicine.
• Haim Jelin, public servant and former Eshkol Regional Council head, for his efforts in strengthening border communities and fostering national unity.
• Adv. Dan Yakir, legal advocate for civil rights, for
his work in landmark cases advancing equality, freedom of expression, and human dignity.
President Prof. Asher Cohen summed up the event: “This year, more than ever, we are proud to recognise an exceptional group of individuals who exemplify the spirit of Israeli society and democracy.”
Israel Prize Laureates
Three distinguished Hebrew University scholars were awarded the 2025 Israel Prize, the nation’s highest honour:
• Prof. Ruth Kark (Department of Geography), for her landmark research in the geography and history of the Land of Israel.
• Prof. Dwora Gilula (Departments of Classical Studies and Theatre History), for her contributions to literature, poetry, and translation into Hebrew.
• Prof. Yinon Ben-Neriah

(Faculty of Medicine), for groundbreaking cancer research that led to globallyused therapies for blood cancer.
• Prof. Yossi Buganim’s lab secured a $600,000 grant from the Leo Foundation to advance research on fibroblast dysfunction and skin rejuvenation—an exciting breakthrough in dermatology.
• Prof. Sergiu Hart was elected an International Member of the U.S. National Academy of Sciences, one of the most distinguished global honours in science. Prof. Hart, a leader in game theory and economic strategy, has profoundly influenced the fields of mathematics and economics through his work at the Centre for the Study of Rationality.
• Dr. Chaim Garfinkel (Institute
of Earth Sciences) was named a 2025 Blavatnik Laureate in Israel for his climate science research. His models offer critical insight into atmospheric behaviour and climate prediction, advancing global sustainability efforts.
• Game design students Evyatar Cohen and Tamir Herzberg earned international acclaim with the Figgie Award for Excellence in Design at the Boston Festival of Indie Games and took home the Bezalel Meisler Prize for 2024.
Left to right: Evyatar Cohen, Tamir Herzberg, Danil Bialo Credit: Karina Bialo
In a landmark moment for Israeli tech, Hebrew University alumni Assaf Rappaport, Ami Lotbek, and Yinon Costica co-founders of WIZ—achieved the largest exit in Israel’s history
through its acquisition by Google. This milestone follows in the footsteps of Mobileye, another startup rooted in Hebrew University innovation
Dual Honors in Law and Society
Two members of the Faculty of Law received the 2025 Landau Prize for Sciences and Arts:
• Prof. Yuval Shany, for his leadership in international law and scholarship.
• Dr. Renana Keydar, for her work with the Edut 710 Project, exploring civic memory and resilience through legal and cultural narratives.
From global scientific research and national honours to worldchanging entrepreneurship, the past year affirms Hebrew University’s vital role in shaping leaders, thinkers, and changemakers who drive Israel—and the world—forward.

The Hebrew University of Jerusalem has, for a century, stood as a beacon of intellectual achievement, advancing knowledge and inspiring innovation across various fields. Its founding was inspired by the vision of Zionist leaders, particularly Zvi Herman Schapira, at the First World Zionist Congress in 1897. Their dream of creating a world-class academic institution in Jerusalem came to fruition on April 1, 1925, when the Hebrew University officially opened its doors.
The opening ceremony, attended by dignitaries from across the world, marked the culmination of decades of thought and over seven years of construction. From the laying of the cornerstones in 1918 to the first classes in 1925, this marked the start of a new era. On a simple wooden stage,

without microphones or amplification, speeches were delivered by Dr. Chaim Weizmann, future president of Israel; Chief Rabbi of Palestine Abraham Isaac Kook; Lord Balfour; British High Commissioner Sir Herbert Samuel; and poet Chaim Nachman Bialik.
Thousands gathered for the event, including prominent leaders, clergy, British military and administrative officials, and international academic delegations. One notable absentee was Albert Einstein, who was in South America giving lectures but sent a handwritten manuscript of his Theory of Relativity to mark the occasion. This manuscript is now preserved in the Einstein Archives, located at the Edmond J. Safra Campus in Givat Ram. Even before the university opened, Einstein remarked in a 1921 interview with The New York Times: “There has been no event in my life that gave me greater

satisfaction than the initiative to establish the Hebrew University in Jerusalem.”
The establishment of the Hebrew University was made possible through the efforts of some of the most visionary intellectuals of the 20th century. Among them were Albert Einstein, Chaim Weizmann, Sigmund Freud, Chaim Nachman Bialik, Martin Buber, and Judah Leib Magnes. These individuals shared a common goal: to create an institution of higher learning that would serve as a centre for academic excellence, cultural identity, and innovation.
The Hebrew University’s legacy is further exemplified by its long history of producing Nobel Prize winners and global leaders. Numerous faculty members and alumni have been recognized with Nobel Prizes across a range of fields, solidifying the university’s status as one of the world’s premier institutions of higher learning.
Among the notable figures who have shaped global
discourse and science are many who began their journey at the Hebrew University, including future Israeli prime ministers, groundbreaking scientists, influential thinkers, and cultural icons. These individuals continue to leave an indelible mark in and in all areas of life.
Perhaps no figure is more closely associated with the Hebrew University than Albert Einstein. The university houses the Albert Einstein Archives, a remarkable collection of over 80,000 documents, many in Einstein’s own handwriting. These include his will, letters, personal correspondences, and original manuscripts of his groundbreaking theories, including the special and general theories of relativity.
Einstein’s bequest to the university was not monetary but intellectual—his personal library and papers provide an invaluable link between his scientific brilliance and the broader cultural and historical context in which he lived. Professor Hanoch Gutfreund, former Hebrew University president and academic head of the Einstein Archives, said, “We have a responsibility to ensure Einstein’s legacy isn’t just remembered but
understood in its full complexity.”
Einstein’s connection to the Hebrew University ran deep. He was a staunch supporter of Zionism, advocating for the establishment of a research university that would contribute to the intellectual and cultural renaissance of the Jewish people. His commitment to education and justice continues to resonate, and his archives serve as a testament to a man who saw science as a tool for understanding humanity and fostering global cooperation.
Another pillar of the Hebrew University’s success is Yissum, the university’s technology transfer company. Yissum has played a pivotal role in translating groundbreaking research into realworld applications. To date, Yissum has registered over 260 startup companies based on universitydeveloped technologies, 18 of which have gone public. Notable successes include Mobileye, a leader in autonomous vehicle technology.
Yissum’s efforts are a testament to the university’s commitment to fostering innovation and building strong partnerships between academia and industry. As the university enters its second century, it remains focused on advancing research, nurturing entrepreneurship, and contributing to Israel’s economy and technological leadership.
As the Hebrew University celebrates its centenary, it stands as a global leader in research and education. In 2024, the university was ranked as the top research institution in Israel and 81st among the world’s top 100 universities according to the Shanghai Ranking.
The Hebrew University’s scope of research spans virtually every field, from space exploration to health sciences, from neuroscience to environmental studies. The university has also cultivated extensive international ties,
with hundreds of research collaborations and student exchange programs that promote global engagement.
Professor Asher Cohen, President of the Hebrew University, reflects on the university’s lasting impact: “For a hundred years, the Hebrew University of Jerusalem has been home to exceptional individuals—those who question, who break conventions, who innovate and redefine boundaries. It all began with a pioneering spark in the heart of Jerusalem, shaping the academic landscape of Israel.”
In the 21st century, the Hebrew University remains steadfast in its mission to foster innovation, educate future leaders, and advance knowledge across diverse disciplines. The university’s commitment to diversity, inclusion, and academic excellence continues to shape its ongoing role in global research and education.

In celebration of the Hebrew University of Jerusalem’s centenary, the university’s senior leadership, together with prominent alumni, opened trading on April 6 at the Tel Aviv Stock Exchange (TASE). The event underscored the university’s impact on Israel’s economy and society, celebrating a century of academic excellence and contributions to innovation.
The ceremonial opening was led by Professor Eugene Kandel, Chairman of the TASE Board of Directors and a Hebrew University professor, alongside Professor Asher Cohen, President of the Hebrew University. Their presence, along with distinguished alumni and business leaders, symbolised the university’s deep-rooted connection with Israel’s financial and business communities. Professor Cohen remarked, “Today’s ceremony highlights the strong bond between academia, industry, and the Israeli economy. Since its founding, the Hebrew University has been a catalyst for innovation, technology, and economic growth.”


Following the opening, roundtable discussions were held with 50 students from the Hebrew University, representing fields such as Business Administration, Economics, Computer Science, and Technology, providing a platform for students to engage with industry leaders.
Rob Schneider, CEO of Australian Friends of the Hebrew University, said, “We are extremely proud to celebrate this remarkable milestone. As we celebrate the centenary of the Hebrew University of Jerusalem, we take immense pride in its extraordinary legacy of innovation, academic excellence, and global impact. For 100 years, the university has pushed the boundaries of science, medicine, technology, and the humanities. Its groundbreaking research and brilliant minds continue to shape the future, making a profound
difference in Israel and around the world. We at the Australian Friends of the Hebrew University are honoured to support this remarkable institution and look forward to the next century of achievement.”
As it enters its second century, the Hebrew University remains steadfast in its mission to advance knowledge, foster innovation, and educate the leaders of tomorrow. With its distinguished history and commitment to excellence, the university will continue to play a vital role in shaping Israel’s academic and scientific future and contributing to the global research community. As Albert Einstein once said, “...support of the Hebrew University in Jerusalem and the maintenance of its high standard are of a decisive importance.” Let us ensure that Einstein’s legacy continues for many years to come.
The Hebrew University’s Centre for Computational Medicine is bridging the gap between data science and patient care, replacing the ‘one size fits all’ model of medical treatment with data-driven, personalised health solutions.
Computational Medicine is a transformative approach to understanding and combatting disease by integrating computational data analysis and artificial intelligence into medical research and practice. Treating disease effectively in the modern era requires the integration of individual patient genetic and molecular profiles with those of thousands of other patients, and the application of algorithms to detect patterns and tailor effective, personalised treatment.
A new Centre for Computational Medicine at the Hebrew University in Jerusalem is revolutionising health care in Israel and has begun to provide vital insights into disease genesis, identify potential targets for therapy and point to protocols for prevention, all while preparing the next generation of computationally trained doctors and researchers. The Centre will constitute the most advanced focal

point of medicine in Israel, radiating its influence throughout the country, and establishing Israel at the forefront of global leadership in biomedical research and treatment.
In many cases, cancer is diagnosed in patients too late in the game – once the cancer has already spread. At that stage of the cancer, the rates of survival drop dramatically.
Professor Yuval Dor and Dr. Ruth Shemer of the Hebrew University of Jerusalem teamed up with Professor Ben Glaser, Head of the Endocrinology Department at the Hadassah Medical Centre, to develop a groundbreaking blood test. A test that


could determine not only if one has cancer, but in which part of the body.
“Our work demonstrates that the tissue origins of circulating DNA can be measured in humans. This represents a new method for sensitive detection of cell death in specific tissues, and an exciting approach for diagnostic medicine,” said Dr. Ruth Shemer.
When cells die, they release DNA fragments into the circulatory system. The blood test developed by Prof. Dor, Dr. Shemer, and Prof. Glaser can analyse these fragments to determine where and why tissue cell death has occurred. This non-invasive test can be the difference between detecting cancer early and discovering it too late.
“In the long run, we envision a new type of blood
test aimed at the sensitive detection of tissue damage, even without a prior suspicion of disease in a specific organ,” said Prof. Benjamin Glaser. “We believe that such a tool will have broad utility in diagnostic medicine and in the study of human biology.”
Doctors perform blood tests regularly, but none this comprehensive. This new test can revolutionize how medicine detects and treats disease. It allows for earlier detection of cancer, diabetes, traumatic injury, neurodegeneration, and other diseases involving abnormal cell death.
Most importantly, this test could significantly improve survival rates by identifying diseases early—when they are still treatable.


Once fully developed, this technology can be used to detect diseases such as Alzheimer’s, Parkinson’s, and diabetes in their earliest stages. The current lack of reliable biomarkers for these diseases is a significant hurdle for early intervention and effective treatment.
Going Forward: A Purpose-Built Facility
Centre scientists will focus on four key health challenges:
• Cancer
• Metabolic diseases
• Infectious and inflammatory diseases
• Aging
Th•is targeted focus ensures that resources and brainpower are directed toward the most urgent




• To integrate big data approaches into biomedical research
• To empower interdisciplinary research in computational medicine
• To provide state-of-the-art infrastructure and technologies
• To attract exceptional young scientists
• To educate the next generation of clinical and research leaders
The Microbiome
Dr. Moran Yassour studies microbial communities using genomic sequencing and computational biology. Her research on the gut microbiome helps us understand its role in pediatric health, including IBD and allergies.
Dr. Oren Parnas uses single-cell analysis to study how cancer cells evade immune detection and how to reprogram immune cells to attack tumours.
Dr. Shahar Arzy applies computational methods to detect early orientation impairments in Alzheimer’s Disease. His work focuses on early identification to prevent or delay disease progression.
Dr. Danny Ben-Zvi uses computational approaches to study obesity-related diseases. His research on the effects of gastric bypass surgery could lead to non-surgical treatments that achieve similar benefits.

In Jerusalem, deliveries, early childhood development, and prenatal care are centralized. This unique setup allows for comprehensive data collection, including biospecimens, wearable tech, and questionnaires. Researchers aim to investigate early predictors of complications such as preeclampsia, postnatal depression, and developmental outcomes.







Hadassah Medical Centre is genotyping and phenotyping 2,000 new cancer patients annually. This large-scale collection of biospecimens and records enables highly individualised cancer treatments using genomics and liquid biopsy technologies.
Hebrew University researchers have made gamechanging discoveries:
• DNA methylation and epigenetics (Cedar, Razin)
• Molecular understanding of blood vessel formation, impacting treatments for cancer and blindness (Keshet)
• Drugs for Alzheimer’s (Weinstock-Rosin) and cancer (Barenholz, Gabizon)
• Liquid biopsies (Dor, Shemer)
The University continues to pioneer new paths in medicine, integrating advanced technologies and innovative thinking.
Hebrew University’s Faculty of Medicine contributes significantly to Israel’s war effort:
• All IDF military physicians are graduates of the Tzameret Elite Military Medicine Program.

• HU Faculty of Medicine has the highest percentage of student reservists among Israeli universities.
The Hebrew University is dedicated to maintaining its tradition of breakthrough discoveries and innovative research in medicine. By uniting computer scientists, biologists, clinicians, and engineers, it is laying the groundwork for a new era of personalised medicine and global health leadership. As life expectancy increases and diseases grow more complex, the Centre for Computational Medicine stands as a beacon of hope and progress—using data to save lives and ensuring a healthier future for all.
The Australian Friends of the Hebrew University is proud to support this project.

David Hilder
The opportunity to study at the Hebrew University of Jerusalem first came to me very accidentally, but it’s been one of the best decisions I ever made. The university and the city have been the most stimulating and transformative experiences for my personal and academic growth, and I will be forever grateful for all the time I’ve spent here.
Boasting one of the top departments in the world in my field of study of Assyriology, I’ve received nothing short of a top-quality education alongside a multitude of exciting study opportunities both inside and outside the university. Working with some of the world’s top professors and scholars of Ancient Near Eastern studies, I’ve quickly reached a high level of proficiency in ancient Mesopotamian languages such as Akkadian and Sumerian. The strong foundation provided by the university and my professors has allowed me to take part in a number of advanced reading courses on a wide variety of ancient cuneiform tablets, ranging from magical incantations to mythologies and mathematical exercises.
Beyond the classroom, I’ve had many unique chances to immerse myself in a number of exciting research projects. I’m working on the Cuneiform in Australia and New Zealand (CANZ) project, which focuses on translating and studying various cuneiform collections back in my home countries. Here in Jerusalem, I’ve also worked on the translation of dozens of cuneiform tablets in-person at the Bible Lands Museum Jerusalem, a rare opportunity to handle and study original artifacts


that have never been read in thousands of years. Another highlight of my time here is developing an encyclopaedia of Mesopotamian astronomical terms-an ambitious and rewarding project blending language, science, and cultural history.
I have been lucky enough to explore much of this country between my studies. From the most exquisite wineries around Jish in the north, to the many archaeological sites across the Judean mountains in central Israel, to ancient petroglyphs scattered across the vast Negev. A single day trip during this year’s Pesach break took me to Ein Yorkeam, a refreshing spring hidden in the middle of the Negev desert, followed up by a hike across the stunning Makhtesh HaKatan, and finally ending the day cooling off nearby the Ein Gedi beach on the Dead Sea. All this for a one day trip from Jerusalem! It never ceases to amaze me just

how much there is to see and experience in this place- one could spend years exploring even a tiny corner.
Living in Jerusalem has also brought countless unexpected gifts. It’s a city that lives and breathes history, where ancient and modern coexist in a way that constantly challenges me to engage more with life here. Experiencing such a multitude of religions, cultures, histories, and languages in such a small area is nothing short of inspiring. Just recently, experiencing the wonders of Purim, Ramadan, Pesach, and Easter all so close to each other in the holy city is a really special thing. There’s an intensity of life and a depth of tradition that permeates every corner of the city- even the shortest walk in any direction results in an encounter with some ancient structure or place of great religious or cultural significance.
More than just a place where I came to study, Jerusalem has also become my home. I’m incredibly grateful for the many friendships, the mentorship, and the countless wonderful memories I’ve made here. My time in Jerusalem has not only advanced my academic career- it’s fundamentally reshaped the way I see the world and my place in it.
Although my time here is ultimately limited, I know I’ll be seeking future opportunities to return me to this place that has impacted me so deeply.
Thanks to the generosity of visionary donors, the Australian Friends can offer limited financial assistance to Australian students studying at the Hebrew University who meet certain conditions. Donations to the Australian Friends of the Hebrew University Scholarship Fund are fully tax deductible.


encouragement of many, including and especially Australian University.
I am extremely grateful for this incredible experience. and inspiring and taught me so many invaluable lessons. understanding of Jewish history, Jewish law, modern Israeli geographic history
I feel very privileged that I was able to undertake this study a challenging and unique time in Jewish history The experience something I would highly recommend.
University in Jerusalem, and I planned to undertake an exchange program in the second semester of 2024. However, following the devastating war that began on October 7, 2023, my university paused exchange programs in Israel, precluding me from going.
Although I was initially disappointed and frustrated, I was determined to find a way to still fulfil my dream. After much liaising with both my university in Australia and Hebrew University, I managed to organise an independent study abroad experience. I had the privilege of spending six months in Israel, during which I attended the Rothberg International school for a semester.

This experience was informative, meaningful and very fulfilling, and would not have been possible without the assistance, support and encouragement of many, including and especially Australian Friends of Hebrew University.
I am extremely grateful for this incredible experience. The educators were outstanding and inspiring and taught me so many invaluable lessons. I gained a deeper understanding of Jewish history, Jewish law, modern Israeli society and
I feel very privileged that I was able to undertake this study, and especially during such a challenging and unique time in Jewish history. The experience was life changing and something I would highly recommend.
Thanks to the generosity of visionary donors, the Australian Friends can offer limited financial assistance to Australian students studying at the Hebrew University who meet certain conditions. Donations to the Australian Friends of the Hebrew University Scholarship Fund are fully tax deductible
We were very fortunate to have the remarkable Prof. Gila Kahila Bar-Gal on sabbatical in Sydney.
Prof. Kahila Bar-Gal is a professor at the Hebrew University of Jerusalem, serving as the head of the Molecular Evolution Laboratory, at the Koret School of Veterinary Medicine. Additionally, she holds the position of Director of the National Natural History Collection of the Hebrew University and is certified by the Society of Wildlife Forensic Science (SWFS) as a Wildlife Forensic Scientist. Gila’s research crosses evolution, co-evolution, animal domestication, anthropology, human ecology, conservation genetics, modern technologies in research and conservation of cultural heritage and wildlife forensics. Gila has examined and identified animal DNA from the Dead Sea Scrolls, trained dogs to smell cancer, worked with Interpol in international animal smuggling cases, and still, there is so much more to the life and career of this remarkable woman.
Gila generously gave her time to speak to a variety of audiences in Sydney, Melbourne and Perth with major events in conversation with journalist Gemma Tognini, Zionism Victoria’s Zeddy Lawrence and SKY News journalist Caroline DiRusso respectively.
The events were titled Unearthing Stories, and each audience was enthralled by Gila’s fascinating and diverse career, research and achievements spanning evolution, co-evolution, animal domestication, anthropology, human ecology, conservation genetics, modern technologies in research and conservation of cultural heritage and wildlife forensics.

Gila related to her interviewers how her unique skill of extracting DNA from ancient bones made her a key figure in the identification of victims of the October 7 massacre. Many of the victims’ remains were severely burnt and DNA extraction was exceedingly difficult. Gila joined forces with a one-time rival to set up a lab to fast track the identification of hundreds of specimens to help bring closure to the victims’ families. Initially, Gila recognised the names of many of the victims as she had lived on a kibbutz near the Gaza border. To continue her harrowing work, she requested that the specimens be given to her with case numbers instead of names. Gila said, “The only thing that drove us was that there were families waiting for answers, and we were the only ones that could help them get answers, and so you do it.”



Michael Dunkel, Gary Perlstein, Gemma Tognini, Gila Kahila Bar-Gal, Robert Schneider, Rabbi Levi Wolff
Gemma Tognini reflected “We were in conversation for an hour, but I could have spoken all night. What a privilege, a deeply and profoundly impacting experience.”
The Australian Friends are deeply grateful to Gila for all her contributions in her short time in Australia and she has left as a true friend to us all.


For a century, the Hebrew University of Jerusalem (HUJI) has been at the forefront of innovation, academic excellence, and global impact. With six campuses, 24,000 students, and partnerships with top universities worldwide, HUJI isn’t just Israel’s premier institution - it’s a launchpad for bold ideas, groundbreaking research, and future leaders.

The Hebrew University is a leader in scientific and technological breakthroughs, with top-tier research centres in nanotechnology, artificial intelligence, climate science, cybersecurity, and medicine to name but a few. Through Yissum, its tech-transfer company, HUJI turns cutting-edge discoveries into real-world solutions, fuelling Israel’s reputation as the “Start-up Nation.”
From revolutionary cancer treatments to the invention of the cherry tomato and advancements in artificial intelligence, HUJI innovations continue to shape industries and improve lives worldwide.
HUJI has always been a magnet for bright minds. Founded in 1925 by visionaries like Albert Einstein, Sigmund Freud, and Chaim Weizmann, the University was built as a centre of knowledge and progress for the Jewish people and the world.
Today, students from over 90 countries call HUJI home, benefiting from its renowned international programs. At the Rothberg International School, students experience a unique blend of academic excellence and cultural immersion in Jerusalem - a city where ancient history meets modern vibrancy.
Studying in Israel is about more than academicsit’s about growth, discovery, and finding your place. At the Hebrew University, you’ll join a diverse, inclusive community where you can express your identity, pursue your passions, and build lifelong connections.




From 24/7 support at our Welcome Centre to exciting tours, activities, and cultural programs, HUJI ensures that students experience Israel beyond the classroom. Explore, connect, and create unforgettable memories while shaping your future.
The Hebrew University has strong ties with Jewish communities worldwide, including Australia. Considering a BA at HUJI? Our International BA program lets you earn a double-major degree in just three years, with three tracks to choose from: English & Business Administration, Business Administration & Liberal Arts, and Liberal Arts & English.
Australian students have exciting opportunities to benefit from a range of scholarships and financial assistance when studying at HUJI. Through the support of the Australian Friends of the Hebrew University, limited conditional assistance is available for students who are Australian citizens, plan to return to Australia after completing their
studies, and are committed to helping promote the University’s mission in Australia. Dedicated scholarships include the Golimdja William Cooper Memorial Scholarship, which supports Indigenous Australian students pursuing a specified Master’s program by covering tuition, accommodation, and a food stipend.
Beyond these opportunities, HUJI offers a wide range of scholarships for international students across all programs, including full scholarships in STEM fields (graduate and post-graduate studies). Additional support is available through the University’s International Office, including Open Day scholarships, Merit Scholarships, the Rothberg Family Fund, and Masa Israel Journey support (subject to eligibility).
Students enrolled in our international BA program also enjoy an unparalleled student experience, with free membership to the nearby country club for three years, giving access to excellent gym and pool facilities, and the option to enhance their language skills through Hebrew Ulpan courses at an additional cost.

With limited spots available, interested students should apply early!
“Studying my Master’s in Assyriology at Hebrew University has been an incredible experience. Jerusalem, at the crossroads of three continents, is layered with history, cultures, and languages — it’s the perfect place to study the ancient world. Life at HUJI is diverse, vibrant, and full of opportunities. The professors are friendly, approachable, and truly supportive, especially of international students — I was even invited to a Friday night Shabbat dinner with my professor’s family! Living at the Student Village, just a short walk from campus and a quick bus ride to the city center, has made everything so easy and exciting. I can’t wait to see what’s next.”
— David Hilder, Australia
In addition to full-degree programs, Australian students can take advantage of HUJI’s dynamic short-term summer opportunities, which


align well with the Australian university break calendar. Programs in science, innovation, and entrepreneurship include the Transdisciplinary Innovation Program (TIP), the Science Internship Program, InnovNation, and specialised courses such as Start-Ups & Innovation: The Israeli Model and Breakthrough Technologies: Shaping the Future. Those looking for a meaningful gap experience may consider the new four-week Volunteer Program in September, run in collaboration with Masa Israel Journey. Open to eligible participants for just $150 (excluding flights), the program combines hands-on community volunteering, travel across Israel, cultural immersion, and the opportunity to earn academic credit.
The Hebrew University champions inclusivity, diversity, and equal opportunity across Israeli society. Programs supporting ultra-Orthodox Jews, Arab students, and individuals with disabilities reflect its commitment to a more equitable future.



But HUJI’s mission goes further - it actively applies knowledge to improve lives. The University’s legal, medical, and social work faculties engage directly with the community, providing free legal aid, medical services, and educational programs to underserved populations.
As the Hebrew University celebrates its centennial, it is not just reflecting on a century of achievements but looking ahead. With investments in groundbreaking research, expanded global collaborations, and solutions for 21st-century challenges, HUJI remains at the forefront of innovation.
Centennial celebrations will bring together alumni, scholars, and friends worldwide to honour the past and shape the future. From academic conferences to cultural events, the festivities will highlight HUJI’s impact and commitment to education and research.
The Hebrew University’s centennial is more than a celebration - it’s an invitation to be part of its future. Whether you engage through academic collaborations, philanthropy, or by sharing HUJI’s impact, you can help shape the next 100 years of excellence.
For Australian Jews, whose deep ties to Israel and its institutions have spanned generations, this is a unique opportunity to strengthen your connection with HUJI and play an active role in its ongoing success.
Be part of HUJI’s next 100 years - explore worldclass academics, global opportunities, and a vibrant student life in Jerusalem. Australian students can find their place at HUJI! Learn more at one of our digital open days [https://tinyurl.com/3t9vc2zc] or contact us at contactus@mail.huji.ac.il to explore your opportunities.
Together with these scholarships, covering both Bachelor’s and Master’s programs, the Hebrew University has established a dedicated fund to ensure children who were held hostage can access higher education in the future. The initiative includes personalised academic guidance, psychological support, and career counselling, aiming to provide a foundation for their recovery and reintegration, while reflecting the university’s deep commitment to social responsibility and the transformative power of education. The program is designed to serve as a cornerstone for these individuals’ return to normalcy, equipping them with the tools to achieve their personal and professional aspirations.
The university emphasises not only the academic aspect of this initiative but also the importance of creating a warm, supportive community. This holistic approach aims to restore a sense of belonging, rebuild self-


In a transformative step toward healing and renewal and to support the rehabilitation and recovery of individuals who endured captivity in Gaza, The Hebrew University of Jerusalem is offering full scholarships for a three-year academic degree in any field of study to all released hostages.
confidence, and facilitate a smoother transition back to everyday life. The initiative also sends a broader message of unity, encouraging Israeli society to extend its support to those who endured unimaginable trauma.
Prof. Tamir Shefer, Rector of The Hebrew University, stated: “We are committed to standing by all who experienced the horrors of October 7th and the prolonged captivity under Hamas. It is our responsibility to support them in every way possible. We aim to help them rebuild a hopeful future and provide a solid anchor in their long rehabilitation journey. As Israel’s leading academic institution, we believe in the transformative power of higher education and its potential to drive personal and societal change. This initiative reflects our deep ethical and social commitment.”
This program complements a range of efforts undertaken by The Hebrew University since October 7th to assist reservist students and their families, students displaced from their homes, and prospective students who served as combat soldiers. These efforts include significant resource allocations, doubling courses, and dedicating specialised staff, underscoring the university’s unwavering commitment to bridging academic excellence with profound social responsibility.

Peter and Anne Fuchs and the Fuchs Family, along with CSM Sec P ty Ltd would like to wish Mazal Tov to the Hebrew University on turning 100!
We're proud to be par t of the celebration.




Scientists have uncovered a powerful ally in the fight against neurodegenerative diseases: a nucleolar complex that plays a pivotal role in maintaining cellular health through protein homeostasis (proteostasis), by which cells maintain the balance and proper functioning of their proteins. By suppressing this complex, researchers have shown it’s possible to dramatically reduce the toxic effects of Alzheimer’s-causing proteins, boosting the cell’s natural defenses through enhanced degradation of hazardous proteins. This mechanism regulates proteostasis across tissues by modulating TGF-β signaling, a pathway involved in cell growth, differentiation, and tissue homeostasis. This breakthrough opens exciting new possibilities for the development of new therapies that could slow or even prevent diseases like Alzheimer’s, offering hope for a future of healthy aging.
As we age, the intricate balance of protein homeostasis (proteostasis) — the system responsible for maintaining cellular health by ensuring proteins are correctly folded— begins to falter. This decline leads to the accumulation of toxic protein aggregates, a hallmark and an underlying cause of neurodegenerative
diseases such as Alzheimer’s disease. A new study led by Hebrew University researchers Prof. Ehud Cohen and the student Huadong Zhu from the Department of Biochemistry and Molecular Biology at the Institute for Medical Research Israel–Canada (IMRIC) in collaboration with the lab of Dr. Yonatan Tzur of the Alexander Silberman institute of Life Science, sheds light on a promising new way to address this issue, with implications that extend far beyond basic research.
The research identifies that a nucleolar complex, FIB-1-NOL-56, is a central player in the regulation of proteostasis at the cellular and organismal levels. By suppressing the activity of this complex, the team observed a marked reduction in the toxic effects of Alzheimer’sassociated Aβ peptide and another diseasecausing protein, in model organisms. This discovery not only deepens our understanding of how the body manages cellular stress but also offers hope for future treatments that could delay or prevent a myriad of devastating neurodegenerative diseases.
“Our findings go beyond the lab bench,” explains Prof. Cohen. “Neurodegenerative diseases

affect millions of people worldwide, impacting families and caregivers. By uncovering how cells communicate to maintain protein integrity, we’re opening the door to the development of preventive therapeutic approaches that could delay disease onset and significantly improve quality of life of the elderly”.
This research has a real-world relevance that’s hard to ignore. Neurodegenerative diseases like Alzheimer’s disease touch nearly every family, affecting not just patients but also their loved ones. The ability to slow or prevent these conditions could mean more meaningful moments with aging parents, fewer health crises, and a longer period of independence for
millions of older adults.
As the team looks ahead to translating these discoveries into treatments, the potential to improve the lives of countless individuals grows ever clearer. With continued research, this approach could lead to a future where aging does not come hand-in-hand with the spectre of neurodegenerative disease.
The research paper titled “A nucleolar mechanism suppresses organismal proteostasis by modulating TGF-β/ERK signaling” is now available in Nature Cell Biology and can be accessed at https://doi. org/10.1038/s41556-024-01564-y
Israel Aerospace Industries, the Israel Innovation Authority and Hebrew University have Launched Israel’s First Quantum Computer Built with Superconductor Technology

Israel’s first domestically built quantum computer, utilising advanced superconducting technology, is now operational. The 20-qubit quantum computer was developed under the leadership of the Israel Innovation Authority, Israel Aerospace Industries (IAI), Hebrew University, and the university’s technology transfer company, Yissum. This collaboration established a superconductor-based quantum computer infrastructure alongside a robust development and integration environment. These advancements mark a strategic knowledge foundation for Israel, supporting both defence and civilian applications.
The global race for “quantum supremacy” has accelerated in recent years with groundbreaking discoveries in the field. Now, Israel is among the leading nations building

quantum infrastructures and computers that promise to revolutionise computing across research, defence, industry, and more. IAI has invested substantial resources into its quantum efforts, establishing itself as a major player in the field with the unveiling of Israel’s first blue-and-white quantum computer. Quantum QHIPU’s quantum computer lab will focus on design, simulation, integration, and the adaptation of practical applications for the superconducting quantum computer. This work includes collaborations with companies and research institutes globally, positioning Israel at the forefront of quantum computing. The tight coordination among government, academia, and industry provides a significant edge over international competitors and strengthens Israel’s position as a leader in quantum technology.

Yishai Fraenkel, Director-General of the Hebrew University, stated: “The research team working on this ambitious project is among the best at the Hebrew University. The collaborative, multidisciplinary nature of this project will yield critical outcomes for research and bolster Israel’s scientific and technological status. As the Hebrew University celebrates its 100th anniversary, this achievement aligns with our founding mission: from establishing Israel’s first scientific research institute in 1925 on the Mount Scopus campus in Jerusalem to the launch of the country’s first quantum computer.”
Boaz Levy, CEO of Israel Aerospace Industries, added: “Quantum technologies are set to fundamentally elevate human capabilities across a wide range of fields. IAI
is proud to lead Israel toward becoming a global quantum power. In recent years, IAI has developed initiatives in robotics, autonomy, cybersecurity, and artificial intelligence, integrating them into our business lines, some in collaboration with startups and academia. Sustaining the strength of Israel’s defence industries relies on partnerships among academia, startups, industry, and government bodies. Technology is learned in academia and applied in industry, serving as a powerful force multiplier for Israel. To win on future battlefields, Israel needs advanced technologies. IAI’s mission is to stay one step ahead of our adversaries, anticipate emerging threats and develop solutions even before these threats materialise.










Dror Bin, CEO, the Israel Innovation Authority, said: While development of the quantum computer still has a long way to go, it brings with its tremendous technological potential to enhance the computing power available to humanity, accelerating the R&D process on an unprecedented scale. This power will have a dramatic impact on science and the global hi-tech industry. Israel, as a world innovation leader, must remain on the cutting edge of these developments. The unveiling of Israel’s first quantum computer is an important milestone. This is not an isolated
initiative, but part of a broad strategy led by the Israel Innovation Authority to promote breakthrough technologies in a variety of fields. The R&D lab for quantum computing, which we launched in Tel Aviv earlier this year, is a key component of Israel’s research and development infrastructure. All of these efforts are part of a nationwide, strategic plan for quantum computing, aimed at maintaining Israel’s technological leadership, preserving the competitive edge of Israel’s hi-tech industry and bringing about sustained economic growth.
A new study at the Hebrew University has revealed that a balanced diet is crucial for the health and task performance of honeybees. The research shows that an unbalanced diet significantly delays the onset of nursing, reduces nursing frequency, and alters care for larvae. These findings highlight the importance of maintaining a balanced diet for honeybees to ensure their efficiency and survival, especially in cultivated landscapes with limited nutritionally balanced pollen sources.

The study has revealed that a balanced diet is essential for the optimal health and task performance of honeybees, a key species for pollination and ecosystem stability. The study, led by Prof. Sharoni Shafir from the Robert H. Smith Faculty of Agriculture, Food and Environment, investigates how honeybees balance their nutritional intake to maintain homeostasis and enhance fitness. The findings indicate that an unbalanced diet with a high omega-6:3 ratio (5:1) significantly affects the bees’ ability to nurse larvae, delaying the onset of nursing, reducing the frequency of nursing visits, and altering the attention given to larvae of different ages.
To test these effects, one-day-old adult worker bees were fed either a balanced diet or an
unbalanced diet for seven days. The bees were then released into a common-garden hive, tagged with barcodes, and continuously filmed for six days. The analysis revealed that those on the unbalanced diet exhibited delayed nursing behavior and reduced efficiency in caring for larvae, particularly in differentiating between three-day-old and four-day-old larvae.
“Balanced nutrition is fundamental for honeybee colonies, impacting not just individual health but also the overall efficiency and survival of the hive,” said Prof. Shafir. “Our study underscores the importance of maintaining a balanced omega-6:3 ratio in the diet of honey bees to ensure they can perform their crucial roles within the colony effectively.”

The implications of this research are farreaching, particularly in cultivated landscapes where the availability of nutritionally balanced pollen sources may be limited. The shift towards a greater omega-6:3 ratio in these areas could pose a significant threat to bee populations, affecting their health, cognitive abilities, and ability to sustain their colonies. “This study opens new avenues for further research linking fitness-related behaviors to nutritional balancing in honeybees,” added Prof. Shafir. “It also highlights the need for conservation efforts to ensure diverse and nutritionally adequate pollen sources are available for these essential pollinators.”
The research aligns with broader findings in other species, where nutritional imbalances are known to affect survival, reproductive success, and offspring health. It calls for increased awareness and measures to support the nutritional needs of honeybees, essential for maintaining their populations and the vital pollination services they provide.
The research paper titled “Unbalanced dietary omega-6:3 ratio affects onset of nursing and nurse–larvae interactions by honey bees, Apis mellifera” is now available in Animal Behaviour and can be accessed at https://doi.org/10.1016/j. anbehav.2024.05.007.
A recent study at the Hebrew University has developed a novel method to analyse genetic variations in families with a high incidence of breast cancer. By examining 1218 genetic variants in 12 families, the research identified 80 genes linked to an increased risk of the disease. It also highlighted the significant, yet previously overlooked, roles of peroxisomal and mitochondrial pathways in breast cancer predisposition and patient survival.
Breast cancer is the most common malignancy among Western women, with up to 10% of cases attributed to genetic variants. Despite this, the roots of many familial cases remain unexplored, largely due to the complex nature of the genetic factors involved. Addressing this critical gap, a recent study led by Prof. Dina Schneidman-Duhovny from the Rachel and Selim Benin School of Computer Science and Engineering at the Hebrew University of Jerusalem has provided new insights into the genetic underpinnings of familial breast cancer, especially prevalent in families of Middle Eastern descent.

The study utilises an innovative analysis method tailored for examining genetic variations in families with a history of breast cancer. This method combines cutting-edge machine learning with detailed analysis of protein structures to investigate rare genetic variants. Through the examination of 1218 variants found among members of 12 families, researchers identified 80 genes that could significantly influence breast cancer risk. This discovery includes 70 genes previously unknown to be linked to breast cancer, significantly expanding our understanding of the genetic landscape of the disease.


Hereditary or familial breast cancer accounts for about 15% of all breast cancer cases. Historically, mutations in well-known genes like BRCA1 and BRCA2 have been linked to increased risks of familial breast and ovarian cancer. Yet, they only account for about 30%40% of familial breast cancer cases. This leaves a substantial number of cases with unknown genetic origins, particularly in families where the illness is evident across generations.
The study revealed key roles for certain cellular pathways related to peroxisomes and mitochondria in predisposing individuals to
breast cancer and affecting patient survival. These pathways were found to be particularly significant across a diverse range of ethnic groups in seven of the families studied, highlighting the broader applicability and importance of the findings.
The researchers used full genome sequencing and AI analysis to study genetic variations in women from Middle Eastern families. This approach identified significant genetic changes, linking subgroups of genes to critical cellular pathways involving peroxisomes, which play a key role in fat metabolism.
Prof. Schneidman-Duhovny remarked, “Our research not only sheds light on the elusive genetic factors behind familial breast cancer but also heralds the possibility of new, targeted treatment strategies that could eventually benefit a wider array of patients, particularly those from underrepresented groups.”
These discoveries open up potential avenues for genetic testing and the development of targeted therapies, promising a significant impact on the management and treatment of breast cancer across diverse populations. Additionally, the findings may eventually support the creation of a specialised genetic testing panel for these patient groups, enhancing early detection and personalised treatment plans as research progresses.

The research paper titled “Discovering predisposing genes for hereditary breast cancer using deep learning” is now available at Briefings in Bioinformatics and can be accessed at https://doi. org/10.1093/bib/bbae346

A new study reveals that physiological synchrony, the alignment of physiological responses between individuals, significantly enhances perceived romantic attraction. Findings show that some individuals are Super Synchronisers- naturally, synchronise well in social and nonsocial contexts, and that super synchroniser are perceived as more romantically appealing. This paves the way for further research into how physiological and behavioural synchrony can broadly shape human relationships.

The study led by Dr. Shir Atzil and her team from the Department of Psychology at the Hebrew University unveils intriguing insights into the mechanisms of romantic bonding, focusing particularly on physiological synchrony—the alignment of physiological responses between individuals—and its impact on perceived romantic attraction.
Physiological synchrony refers to the alignment of physiological responses between individuals. This can include parameters like heart rate, respiration, and skin conductance. When two
people are physiologically in sync, their bodily functions align in a way that is measurable and often occurs naturally during interactions.
The research integrated both experimental and observational methods to investigate how physiological synchrony influences romantic appeal. An online experiment involving 144 participants demonstrated that inducing synchrony between actors significantly boosted their attractiveness ratings. Further investigations in a lab-based speed-dating scenario with 48 participants identified

individuals with a naturally high propensity to synchronise in both social and nonsocial contexts, termed ‘Super Synchronisers’. These individuals were consistently rated as more romantically appealing, underscoring the potential of physiological alignment to significantly enhance perceived attractiveness.
Dr. Atzil explains, “Our findings suggest that the ability to synchronise with others might not just be a social skill but could stem from more fundamental sensorimotor abilities that require an individual to adapt themselves to dynamic
inputs. This adaptability, whether in response to social cues or rhythmic patterns, is perceived as attractive, potentially because of the beneficial physiological consequences a synchronous partner can have.”
The study proposes that synchronised physiological states can improve regulation across various bodily systems, making these interactions more fulfilling. Additionally, effective synchrony may indicate cognitive and evolutionary advantages, suggesting a deeper biological importance of this trait.

Subscribe to the AJN at subscribe.jewishnews.net.au/signup
Get the latest news on australianjewishnews.com
Download the Australian Jewish News App on Apple/ Android devices
Subscribe to the AJN ’s weekly e-newsletter at australianjewishnews.com/signup/
Find us on Facebook
Follow us on







Stay connected with the latest news and current affairs from Australia and Israel through our comprehensive print and digital platforms. We remain committed to being the voice of the Australian Jewish community.



Despite these promising insights, Dr. Atzil notes the limitations of the research. “The crosssectional design of our study limits our ability to draw definitive conclusions about the long-term stability of synchrony as a trait and its causal relationship with romantic attraction,” she remarks. Future research will delve into these dynamics more deeply, especially considering the implications of synchrony in sustained romantic relationships and across different sexual orientations.
This study not only advances our understanding of romantic attraction but also paves the way for further exploration into how physiological and behavioral synchrony can shape human relationships in broader contexts.
The research paper titled “Social and nonsocial synchrony are interrelated and romantically attractive” is now available in Communications Psychology and can be accessed at https://doi. org/10.1038/s44271-024-00109-1
A new study provides important insights into how T-cells, a type of immune cell, become activated. Researchers employed a technique called Bayesian metamodeling, which combines data from different sources, including advanced microscopy and simulations, to analyse the activation process more effectively. This research accounts for a surprising pattern in how immune cells communicate and signal to one another. Understanding this pattern could deepen our knowledge of cellular behaviour and the mechanisms behind immune responses, potentially leading to improved treatments for various diseases.

The study at the Hebrew University of Jerusalem, led by Yair Neve-Oz from the Racah Institute of Physics and School of Computer Science and Engineering, Dr. Barak Raveh from the School of Computer Science and Engineering, and Eilon Sherman from the Racah Institute of Physics, has made an important breakthrough in understanding how immune cells known as T cells are activated. By using an innovative approach called Bayesian metamodeling, the team combined data from advanced super-resolution microscopy techniques and stochastic computer simulations to reveal new, intricate patterns in early T-cell signalling.
T cells are key players in the immune system, responding specifically and efficiently to
threats. Specifically, T cells act as sensitive agents that can identify the presence of infected or cancerous cells, and efficiently clear them. However, until now, existing microscopic models have only partially captured the molecular processes behind early T-cell activation, leaving gaps in our understanding. The Hebrew University team’s metamodel brings these models together, drawing from data on how critical molecules—T-cell receptors (TCR), CD45, and Lck—interact and move at the initial points of contact between T cells and target cells.
A key discovery in a previous study from the Sherman lab (https://doi.org/10.1016/j. celrep.2019.11.022) is a nanoscale ring of activated TCR molecules, surprisingly



appearing around the edge of initial T cell contacts and framed by a ring of CD45 molecules. This pattern could not be explained by current models of T cell activation. The researchers suggest that this pattern arises because Lck molecules, which help transmit signals between TCR and CD45, are restricted in their activity range. This limitation plays a crucial role in how TCRs get activated during the early immune response.
The team also analysed how variations in Lck activity, specific antigen strengths, and forms of CD45 impact T-cell activation. These findings offer a more complete view of early T-cell signaling, with potential applications in understanding other complex cellular processes. Bayesian metamodeling, by

integrating different models into a cohesive whole, offers a powerful tool for uncovering the hidden patterns that drive cellular behavior, with broad implications for immunology and medical research.
This study represents a significant advance in immunology, shedding light on the intricate cellular dynamics that underpin our immune responses.
The research paper titled “Bayesian metamodeling of early T-cell antigen receptor signaling accounts for its nanoscale activation patterns” is now available in Frontiers in Immunology and can be accessed at https://doi.org/10.3389/fimmu.2024.1412221
A recent study at the Hebrew University reveals that the early architectural development in the Near East was far more complex than previously thought, challenging the traditional narrative of a straightforward transition from round to rectangular structures during the Neolithic period. The research introduces a novel computational approach to analyse architectural remains, providing an objective and repeatable method for examining building outlines. This methodology uncovers insights that qualitative methods might overlook, including quantification of defined angles in structures as early as the Natufian period, suggesting advanced building techniques were in use earlier than believed. The study also highlights the architectural diversity during the Natufian and early Neolithic period, suggesting that building codes and more standard practices had not yet emerged. These findings provide new insights into the social and technological changes accompanying the rise of permanent settlements and agricultural economies.
The study led by researchers from the Institute of Archaeology at the Hebrew University—Hadas Goldgeier, Dr. Antoine Muller, and Prof. Leore Grosman—introduces a new computational method to analyse the architectural development of early settlements. By offering an objective and repeatable approach to examining architectural remains,


the study gives a new perspective on the transition from round to rectangular structures during the Neolithic period in the Near East.

Architectural forms have long been tied to societal shifts such as changes in social organisation, demographics, and economic strategies. However, traditional interpretations of early architecture have relied on qualitative methods, which may oversimplify complex trends. This study provides a fresh perspective by digitising building outlines and employing computational tools to objectively quantify their two-dimensional morphology. Using measures like the directionality of normal vectors and minimum angles, the team analysed 118 structures from 23 sites across the Mediterranean region and Jordan Valley, dating
from the Natufian culture to the early Neolithic (15,000–8,500 years ago).
The results revealed a far more nuanced picture than the conventional “round-torectangular” narrative suggests. Structures with right angles, previously associated with later architectural phases, were found as early as the Natufian period, reflecting significant advances in building technology at an earlier stage than previously thought. Moreover, the variability in structure shapes was highest during the Natufian and early Neolithic periods, reflecting a lack of formalised conventions. Later in the





















Neolithic, however, architectural forms showed greater uniformity, potentially signalling the emergence of codified building traditions.
This study not only challenges traditional interpretations but also highlights the social and technological changes accompanying the transition to permanent settlements and agricultural economies. The computational methodology offers an innovative lens to understand architectural history, demonstrating how quantitative analyses can uncover trends that remain hidden in qualitative approaches.
By emphasising the dynamic variability and technological ingenuity of early builders, this research sheds new light on the inception of architecture in the Levant and underscores the importance of integrating modern analytical tools into archaeological studies.
The research paper titled “A computational perspective on the dynamics of early architecture” is now available in Archaeological Research in Asia and can be accessed at https://doi.org/10.1016/j. ara.2024.100571
A new study reveals that typically developing twins consistently take on the dominant role over their nontypically developing siblings, even after developmental gaps are resolved. By highlighting how parental perceptions shape these dynamics, the research offers fresh insights into the delicate balance of twin relationships and the importance of fostering equality to support both children’s growth.

The study conducted by Prof. Ariel KnafoNoam and Dr. Yonat Rum from the Hebrew University of Jerusalem, alongside Dr. Hila Segal and Adi Barkan from The Academic College of Tel-Aviv–Jaffa, sheds light on how developmental differences influence the dynamics of dominance in twin relationships throughout childhood. Twins, unlike singletons, share the same age and often a similar environment, creating unique relational dynamics where traditional factors like birth order play no role. This study, published in Family Relations, explored how differences in developmental conditions between twins, particularly when one child has a developmental condition and the other does not, affect their dominance dynamics over time.

The research surveyed over 1,500 parents of monozygotic and dizygotic twins aged 3 to 9. It found that when one twin was typically developing and the other had a developmental condition, parents consistently perceived the typically developing twin as the dominant sibling.
This dominance imbalance was stable throughout childhood, even in cases where the developmental challenges of the nontypically developing twin were resolved. In twin pairs where both siblings shared the same developmental condition, whether typical or nontypical, no significant differences in dominance were reported. These findings suggest that it is not the developmental

condition itself, but the asymmetry in abilities between the twins, that drives dominance imbalances.
Parental perceptions played a significant role in shaping these dynamics. The study relied on previous work showing that parents often emphasise differences between twins through what is termed the “contrast effect,” a bias that exaggerates perceived differences. This parental tendency can reinforce dominance roles, affecting how twins interact with one another and shaping their long-term relational dynamics. The findings align with family systems theory, which posits that families function as interconnected units where the behaviour and roles of one member
influence the others. In this context, parental perceptions and behaviours may inadvertently solidify certain roles, such as “dominant” or “submissive,” in twins’ relationships. Interestingly, genetic similarity also influenced dominance patterns. Monozygotic twins, who share nearly identical genetic material, were more likely to display symmetrical dominance relationships compared to dizygotic twins, even in cases where developmental conditions differed. This suggests that genetic factors and personality traits may play a role in shaping dominance behaviours and creating more balanced relationships in identical twin pairs.
The study also revealed that dominance roles established early in life tend to persist,


even when the developmental condition of a nontypically developing twin improves. This persistence can be understood through role theory, which explains how family roles, once established, become ingrained through both behaviour and parental reinforcement. To mitigate the effects of entrenched dominance roles, parents are encouraged to create opportunities for more balanced dynamics. Encouraging twins to engage in relationships outside their twinship, fostering individuality, and providing avenues for the less dominant twin to assert themselves in specific domains can help reduce the long-term impact of these dynamics.
This research offers a nuanced understanding of how developmental differences shape twin relationships and underscores the importance of parental awareness in navigating these dynamics. By addressing these patterns early, parents and caregivers can foster healthier, more balanced sibling relationships that benefit both twins’ social and emotional development. The research paper titled ““You and me”: Parental perceptions on asymmetry in twins’ development and their dominance relationship dynamics” is now available in Family Relations and can be accessed at https://doi.org/10.1111/fare.13104





The study led by Dr. Milan Patra along with Professors Ittai Ben-Porath and Yuval Dor from the Faculty of Medicine of the Hebrew University has revealed that senescent human pancreatic beta cells, which play a crucial role in insulin production, exhibit enhanced functional maturation through chromatin reorganisation. Additionally, the study finds that these cells show increased activity of the interferon pathway which stimulates the immune system. This finding may offer a potential new avenue for tackling type I diabetes.
Background: The Diabetes Challenge
Diabetes, characterised by insulin deficiency or resistance, hinges on dysfunctional pancreatic beta cells, which are responsible for secreting insulin to remove glucose from the blood. Enhancing or preserving the function of these cells is pivotal for developing diabetes treatments. Globally, an estimated 463 million adults, or roughly 1 in 11, grapple with this condition, a figure expected to balloon due to aging populations, urbanisation, poor diets, and sedentary lifestyles. Projections indicate that by 2045, over 700 million could be afflicted, posing daunting challenges to healthcare, economies, and public health efforts. Urgent action is imperative to stem this tide, necessitating effective prevention strategies, better access to care, and innovative treatments.
The study, published in Nucleic Acids Research, demonstrates that a significant portion of adult human pancreatic beta cells activate a gene called p16, which indicates that they are in an aging-like state, termed cellular senescence. Interestingly, these senescent cells, rather than showing signs of dysfunctionality, show elevated levels of genes that are important for their function. Thus, these cells appear to possess a higher level of functionality and maturity compared to their non-senescent neighbors. This is surprising, as previously identified senescent cells in other tissues are generally thought to be dysfunctional and have harmful effects.
By analysing the gene organisation of senescent beta cells, the researchers discovered that they change the packaging of the genes – the chromatin, generating a reprogrammed organisation that allows activation of functionality. Because of this, it appears that the aging beta cells have the ability to release insulin in response to glucose in even larger amounts, which helps regulate blood sugar levels effectively.
This study also found that senescent beta cells have elevated levels of genes that communicate with the immune system. This

response, termed the “interferon response” normally acts to indicate a viral infection to immune cells, recruiting their attack. However, the senescence beta cells activate this pathway in the absence of such infection: it is molecular changes in the cells themselves simulate this response. The potential consequence is increased stimulation of immune cells to attack beta cells, the fundamental process that drives type I diabetes. This means that aging beta cells might help regulate immune responses and could be important for understanding autoimmune reactions in type 1 diabetes. Potentially, blocking this response, or the process of senescence, could be used to prevent the progression of type I diabetes in its early stages.
The discovery that aging pancreatic beta cells can retain high functionality and respond to immune signals challenges the traditional view
that senescent cells are purely detrimental. This new understanding opens the door to potential therapies aimed at preserving or enhancing the insulin-secreting function of beta cells in diabetic patients.
“These findings are pivotal because they suggest that senescent beta cells are not a liability, but may act, in a pre-designed manner, to improve insulin production as we age, countering other detrimental effects,” said Professor Ittai Ben Porath. “Furthermore, if it will be further established that senescence of beta cells is a prominent feature of the early stages of type I diabetes, targeting of these cells through drug treatment could represent a novel approach for preventing autoimmune attack of beta cells.”
Future research plans include delving deeper into the mechanisms driving the increased




Beta cells (marked in green) in the pancreas are organized in structures termed islets. In most adults, it was found that a subset become senescent and display the marker p16, shown here in red. The image shows a typical islet in an adult pancreas. Scale bar = 50 μm.
Senescent beta cells show high levels of proteins that display antigens to the immune system.
Pancreatic islets from adult human subject stained for Insulin (INS) marking beta cells, for p16, and for HLA-I – the system by which cells display antigens to attract immune attack. Blue (DAPI) marks DNA. Arrows indicate p16high cells. Scale bar = 10 μm.
Credit: Nucleic Acids Research

activity of functional-maturation programs in aging beta cells, influenced by chromatin dynamics. A comprehensive understanding of these processes holds promise for the development of targeted therapies aimed at enhancing beta-cell functionality and lifespan, thereby improving the quality of life for individuals grappling with diabetes. Understanding how the process of senescence affects the interaction of immune cells with beta
cells, and whether this is indeed associated with diabetes, may open the door for new treatment approaches.
The research paper titled “Senescence of human pancreatic beta cells enhances functional maturation through chromatin reorganisation and promotes interferon responsiveness” is now available in Nucleic Acids Research and can be accessed at https://pubmed.ncbi.nlm.nih.gov/38682582/

A new study reveals that sibling relationships in families with a child diagnosed with autism share significant similarities with those in families with typical children from the children’s perspectives, showing no major differences in warmth, conflict, rivalry, or relative power. However, mothers perceive unique challenges, reporting less warmth and closeness but also less conflict among siblings. This discrepancy between children’s and mothers’ views highlights the need for a holistic approach in supporting these families, addressing both the typical-like experiences of siblings and the nuanced challenges perceived by mothers, to ensure comprehensive and empathetic support.
The study led by Dr. Yonat Rum from the Seymour Fox School of Education at the Hebrew University and the University of Cambridge with Professors Ella Daniel and Esther Dromi along with student Yael Armony from Tel Aviv University and Prof. Ditza A. Zachor, Head of the Autism Center at the Shamir (Assaf Harofeh) Medical Center and Tel Aviv University provides fresh insights into the dynamics of sibling relationships in families with a child diagnosed with autism. This research explores the unique perspectives of both mothers and siblings, unveiling fascinating findings on how these relationships compare to those in families with typical children.

The study included twenty-nine children, with an average age of 8.78 years, who have younger siblings diagnosed with autism, along with their mothers. This group was compared to forty-six children, averaging 9.12 years of age, with younger typical siblings, and their mothers.

Utilising a mixed-methods approach of both quantitative and qualitative data collection and analysis, both groups completed the Sibling Relationship Questionnaires and participated in interviews, offering a comprehensive view of their sibling dynamics.
According to the children’s reports, sibling relationships across both groups showed remarkable similarities. There were no significant differences in overall warmth, conflict, rivalry, or relative power between siblings, regardless of the presence of autism. This suggests that, from a child’s perspective, having a sibling with autism may not drastically alter the fundamental aspects of their relationship.
The mothers’ perspectives revealed a different layer of complexity. Mothers of children with autism reported less warmth and closeness between their children and, surprisingly, less conflict compared to mothers of typical children, highlighting nuanced challenges and decreased involvement in these sibling relationships.
Additionally, the study found more disagreement between mothers and children in the autism group than in the typical group. Both mothers and children in the autism group reported less intimacy and fewer quarrels between siblings. Interestingly, the qualitative analysis showed that siblings tended to focus on their present experiences, while mothers considered the broader processes in sibling relationships. Discussions in the autism group often referenced various specificities without explicitly mentioning “autism.”
Dr. Yonat Rum emphasises the importance of these findings, stating, “Our research sheds light on the nuanced experiences of siblings and mothers in families where autism is present. Understanding these dynamics is crucial for providing better support and resources to these families.”
Autism spectrum conditions affect a significant portion of the population, with recent estimates indicating that 1 in 36 children in the United States are diagnosed with autism. This translates to millions of families worldwide


“This time, be sure you choose an accountant who adds value.”
Level 14, Tower 2 101 Grafton Street
Bondi Junction, NSW 2022
(Entrance corner Grafton & Grosvenor Streets)
Tel: 02 9389 1600 info@baskinclarkepartners com au www baskinclarkepartners com au
Liability limited by a scheme approved under Professional Standards Legislation
















grappling with the unique challenges that come with raising a child on the autism spectrum. The impact of autism extends beyond the diagnosed individual, affecting the entire family unit. Studies have shown that parents of autistic children often experience higher levels of parental stress compared to parents with typically developing children and siblings of autistic children were also studied mainly as at risk for various psychological outcomes. At the same time, research has shown that for autistic children, growing up with typically developing siblings is associated with better socialcommunicational skills and that growing up as a sibling of an autistic child has a positive effect on the development of cognitive empathy. For autistic children and their families, siblingship is, thus, an essential and meaningful resource, and it is important to learn about the quality of this meaningful relationship.
This study underscores the understanding of these widespread effects and the need for a holistic approach in supporting families with autistic children, considering the diverse experiences and perspectives within these families. It highlights the importance of understanding both the typical-like experiences of siblings and the unique challenges perceived by mothers, ensuring comprehensive support for these families.
The research paper titled “Sibling Relationships in Families of Autistic and Typical Children: Similarities and Differences in the Perspectives of Siblings and Mothers” is now available in Journal of Autism and Developmental Disorders and can be accessed at https://doi.org/10.1007/s10803-023-06222-0.
A new study introduces a novel legal framework for addressing climate change through the lens of unjust enrichment. The study proposes a shift away from traditional tort-based climate litigation towards an approach that focuses on the unjust profits gained from environmentally harmful activities. This unique perspective offers several advantages: it circumvents the challenges of quantifying abstract climate harms, allows for accountability without strict proof of wrongdoing, and provides a means to address environmental violations even when specific damages are difficult to establish. The framework’s importance lies in its potential to overcome longstanding hurdles in climate litigation, offering a more flexible and potentially more effective legal tool for combating the climate crisis. By reframing the issue around unjust gains rather than provable harms, this research opens up new avenues for legal action and policy development in the urgent fight against climate change, making it a significant contribution to both legal scholarship and environmental advocacy.
The climate crisis stands as the most pressing challenge of our generation, yet effective legal responses remain elusive. Political polarisation and the influence of special interest groups have stalled meaningful regulatory action on both national and international levels. Climate litigation, largely based on tort principles, has also faced significant hurdles, yielding limited success. In an article published in the Georgetown Law Journal, scholars Profs. Yotam Kaplan from Hebrew University,
Maytal Gilboa from Bar Ilan University, and Roee Sarel from the University of Hamburg, propose a novel legal framework that positions climate change within the doctrine of unjust enrichment. This approach represents a crucial step toward the potential adoption and success of unjust enrichment claims in climate litigation, providing promising and previously underdeveloped legal mechanisms for effective action.
The authors outline two key benefits of the unjust enrichment doctrine:
Addressing Environmental Violations: When defendants engage in clear environmental violations, but the harms are difficult to quantify, concepts of wrongful enrichment and disgorgement of profit can offer effective remedies. This allows courts to act against those profiting from harmful practices even when the extent of the damage is hard to establish.
Liability Without Wrongdoing: Defendants may not fit the traditional mould of wrongdoers necessary for establishing tort liability. Unjust enrichment concepts provide relevant legal responses in such cases, enabling accountability without the strict requirements of wrongdoing.
The doctrine of unjust enrichment, which focuses on gains rather than harms and relaxes the requirements for wrongdoing, is more compatible with the realities of climate litigation



than tort law. The climate crisis involves abstract and dispersed harms that are difficult to identify, quantify, and attribute to specific actors. Moreover, many activities driving the climate crisis are not currently classified as wrongs or violations of specific legal standards, making tort law particularly unsuitable for addressing these issues.
By contrast, the challenges of climate litigation become less daunting when viewed through the lens of unjust enrichment. The processes contributing to climate change are unjust and yield significant profits for a select few. From a
policy standpoint, applying unjust enrichment concepts to address the climate crisis is a necessary step. An effective legal response must ensure that causing environmental harm carries no financial gain.
The paper titled “Climate Change as Unjust Enrichment” is now available at The Georgetown Law Journal and can be accessed at https://www. law.georgetown.edu/georgetown-law-journal/in-print/ volume-112/volume-112-issue-5-may-2024/climatechange-as-unjust-enrichment/

metamaterials to create whole cuts of meat. The work leverages cutting-edge materials science to overcome the long-standing challenges of replicating the texture and structure of traditional meat while offering a scalable and cost-effective production method that surpasses 3D printing technology.





Metamaterials are composite materials whose properties arise from their structure rather than their composition. By adopting principles typically used in the aerospace industry, the team, led by Dr. Mohammad Ghosheh and Prof. Yaakov Nahmias from Hebrew University, developed meat analogues that mimic the intricate architecture of muscle and fat. These analogues are produced using injection moulding, a highcapacity manufacturing process borrowed from the polymer industry, marking the first time this technology has been applied to alternative meat production.
Central to the innovation are two novel metamaterials: a low-temperature meat analogue (LTMA) that replicates the fibrous texture of muscle tissue, and proteoleogel (PtoG), a plant-protein-stabilised oleogel that emulates the structural integrity and cooking behaviour of animal fat. Together, these materials allow the creation of complex meat cuts, such as steaks, chops, and T-bones, with











remarkable precision and sensory fidelity.
The implications of this technology extend beyond culinary innovation. Unlike existing 3D printing methods for meat analogues, which are slow and expensive, injection moulding offers a transformative leap in scalability and affordability. At large-scale production, this method reduces costs to $9 per kilogram, nearly a quarter of the cost of 3D printing, making sustainable meat alternatives accessible to a broader audience.
Blind taste tests conducted as part of the study revealed the sensory appeal of these products, with participants seemingly unable to distinguish between steak analogue and traditional meat. This milestone signifies a major step forward in consumer acceptance of sustainable protein alternatives, particularly for whole cuts, which represent over half of global meat consumption.
“Our work demonstrates the untapped potential
of metamaterials in food technology,” said Prof. Nahmias. “By harnessing their unique structural properties, we have developed a solution that is not only sustainable but also scalable, addressing the growing global demand for meat while mitigating its environmental impact.”
The study represents a convergence of materials science and gastronomy, offering a blueprint for the future of food production. With livestock farming accounting for over 30% of global freshwater use, innovations like this are crucial for building a sustainable food system. By introducing new metamaterials into the culinary landscape, this research opens new possibilities for designing food products that are as appealing as they are sustainable.
The research paper titled “Metamaterial-Based Injection Moulding for the Cost-Effective Production of Whole Cuts” is now available in Nature Communications and can be accessed at https:// www.nature.com/articles/s41467-024-54939-y

A new study from Hebrew University reveals that marmoset monkeys use specific calls, known as “pheecalls,” to name each other, a behavior previously known to exist only in humans, dolphins, and elephants. This discovery highlights the complexity of social communication in marmosets and suggests that their ability to vocally label each other may provide valuable insights into the evolution of human language.
In a groundbreaking discovery, researchers from Hebrew University have found that marmoset monkeys use specific vocal calls, called “phee-calls,” to identify and communicate with each other. This ability to vocally label others has only been seen in humans, dolphins, and elephants until now.
Naming of others is a highly advanced cognitive ability observed in social animals and, until recently, was known to exist only in humans, dolphins, and elephants. Interestingly, our closest evolutionary relatives,

nonhuman primates, appeared to lack this ability altogether.
In a new study published today in Science, a team of researchers from the Hebrew University, led by Dr. David Omer from the Safra Center for Brain Sciences (ELSC), made a groundbreaking discovery: for the first time, they found that marmoset monkeys use specific calls, called “phee-calls”, to name each other.
To uncover this, the researchers, led by

graduate student Guy Oren, recorded natural conversations between pairs of marmosets, as well as interactions between monkeys and a computer system. They found that these monkeys use their “phee-calls” to address specific individuals. Even more interestingly, the marmosets could discern when a call was directed at them and responded more accurately when it was.
“This discovery highlight the complexity of social communication among marmosets,” explains Omer. “These calls are not just used
for self-localisation, as previously thought— marmosets use these specific calls to label and address specific individuals”.
The study also revealed that family members within a marmoset group use similar vocal labels to address different individuals and employ similar sound features to code different names, resembling the use of names and dialects in humans. This learning appears to occur even among adult marmosets who are not related by blood, suggesting that they learn both vocal labels and dialect from other










together with Peter and Jenny Wohl and family wish the Hebrew University every success on their 100 year anniversary
members of their family group.
The researchers believe that this vocal labeling may have evolved to help marmosets stay connected in their dense rainforest habitat, where visibility is often limited. By using these calls, they can maintain their social bonds and keep the group cohesive.
“Marmosets live in small monogamous family groups and take care of their young together, much like humans do,” says Omer. “These similarities suggest that they faced comparable evolutionary social challenges to our early prelinguistic ancestors, which might have led them to develop similar communicating methods.”
This research provide new insights into how social communication and human language might have evolved. The ability of marmosets to label each other with specific calls suggests they have developed complex brain mechanisms, potentially analogous to those that eventually gave rise to language in humans.
The study opens up exciting avenues for further research into how our own communication abilities may have evolved and what we can learn from these social nonhuman primates.
The research paper titled “Vocal Labeling of Others by Nonhuman Primates” is now available in Science and can be accessed at DOI: https://www.science. org/doi/10.1126/science.adp3757




A new study introduces the Proteome-Wide Association Study Hub, an innovative and powerful tool designed to explore genedisease connections across ninety-nine common diseases. Leveraging machine learning and statistical models, the platform (PWAS Hub) identifies genes linked to specific conditions, with separate analyses for male and female subjects as well as inheritance patterns. This accessible resource is set to advance personalised medicine by providing valuable genetic insights to clinicians, researchers, and the public.
The study led by Professor Michal Linial from the Department of Biological Chemistry at the Hebrew University of Jerusalem, in collaboration with Guy Kelman from The Jerusalem Centre for Personalised Computational Medicine, Roei Zucker from The Rachel and Selim Benin School of Computer Science and Engineering, and Nadav Brandes from the University of California (currently NYU, New York), introduces an innovative tool for exploring gene-disease connections: the PWAS Hub. This resource is based on the novel
approach of the proteome-wide association study (PWAS), which complements traditional genetic analysis methods like the genome-wide association study (GWAS) by focusing on the effects of genetic variations on the biochemical function of all protein-coding genes.
The PWAS Hub is designed to be accessible to clinicians, researchers, and the public, offering an interactive platform to explore gene-disease associations and analyse sex-specific genetic effects. With its focus on complex and prevalent conditions, the PWAS Hub aims to become a vital resource for those interested in the genetic foundations of disease, paving the way toward more personalised and precise medical treatments.
Personalised medicine represents a transformative approach to healthcare, focusing on tailoring medical treatment to the unique genetic makeup of each individual. Rather than one-size-fits-all model, personalised medicine considers a person’s genetic, environmental, and lifestyle factors to guide more effective and targeted interventions. This approach is crucial as it allows for more



precise diagnosis, prediction of disease risk, and optimisation of treatment plans, minimising adverse effects and improving patients’ outcomes. The PWAS approach, designed to enhance our understanding of how genetic variations influence diseases, begins with machine learning models that assess the impact of genetic changes on protein function. These individual estimated are aggregated into a gene-damaging score, identifying genes that may be associated with specific conditions. Finally, statistical analyses in case-control setting from the large population in the UK Biobank identify significant genedisease associations, offering a more refined perspective of genetic contributions to various health conditions.
At the core of this study is the PWAS Hub, a platform that enables users to explore genedisease associations using data from the UK Biobank. Covering ninety-nine common diseases with over ten thousand diagnosed cases each, the PWAS Hub allows for disease-specific genetic exploration with analyses distinguished by sex, for male and
female subjects. It also accounts for different inheritance patterns, including dominant and recessive, as well as pleiotropic effects, where single genes impact multiple conditions.
The PWAS Hub’s capabilities are demonstrated through its analysis of asthma, which has identified twenty-seven genes provide insights into the cellular and molecular mechanisms underlying the disease. Additionally, users can also compare data from the PWAS with GWAS data to visualise sex-specific genetic effects and understand the broader genetic impact on common diseases.
The research paper titled “PWAS Hub for exploring gene-based associations of common complex diseases” is now available in Genome Research and can be accessed at https://genome.cshlp. org/content/34/10/1674 (https://doi.org/10.1101/ gr.278916.123).
“Tasting Upside-Down - An Unusual Sensing Mechanism was Found in Human Bitter Sensing” A new study has revealed that some bitter molecules target their sensor through binding simultaneously at two distinct locations, one outside the cell, and the other inside it. This discovery is fascinating because bitter taste receptors are expressed in extra-oral tissues and the new study shows the potential of our cells to sense not only external but also internal signals, opening up new possibilities for drug design, including asthma and inflammation.

A new study, published in Nature Communications, led by Prof. Masha Niv from the Hebrew University of Jerusalem, Dr. Moran Shalev-Benami from the Weizmann Institute, and Dr. Dorothee Weikert from FAU Erlangen, describes an exciting discovery that changes the way we understand human bitter taste receptors. The research has revealed a hidden “pocket” inside one of the body’s bitter taste receptors, called TAS2R14. This breakthrough could help not only understand how our tongue senses bitterness, but also investigate the physiological roles of bitter taste receptors that are expressed extraorally.
There are many chemically different molecules that trigger bitter taste sensations, and the body uses a family of 25 receptors to detect them. Interestingly, many drugs also activate this bitter taste system.
Unlike most other bitter taste receptors, TAS2R14 is highly “promiscuous,” meaning it can recognise and respond to a wide variety of bitter substances, from vitamins to certain drugs and even odorants. The receptor’s ability to respond to such a diverse array of compounds makes it a subject of great interest for researchers. Until now, however, how exactly TAS2R14 binds to these compounds and triggers a response in the body was not fully understood.
The scientists used an advanced technology in electron microscopy (EM) that allows to see the three-dimensional architecture of proteins in great detail. This technique, called cryo-EM, enabled to solve the structure of TAS2R14 together with flufenamic acid (FFA)—a bitter anti-inflammatory drug that activates TAS2R14. The structure led to a surprising discovery: the drug binds simultaneously at two distinct

positions of the receptor: one copy bound at an extracellular site and the other at the intracellular one. This dual binding, sheds new light on how the receptor interacts with diverse chemical compounds, including those that cause bitterness.
“This discovery gives us a new clue into how TAS2R14 works,” explained Professor Niv. “It’s fascinating because the receptor is not just sensing chemicals from outside the cell, like food or drugs, but also ‘tasting’ what’s happening inside the cell. This new intracellular pocket could be a game-changer in how we design drugs to interact with these receptors.”
“To provide direct evidence for binding of the molecule at different pockets of the receptor, we have developed a new assay, which enables us to measure the binding specifically at the extracellular and the intracellular binding
site, providing a unique tool for site-specific discovery”, says Dr. Dorothee Weikert.
“TAS2R receptors do much more than just help us taste bitterness,” the scientists Lior Peri and Dr. Matzov said. “They are found in many parts of the body and are involved in processes like breathing, digestion, and the immune system. By discovering this new pocket, we’ve opened the door to new ways of designing medications that target these receptors, potentially helping to treat conditions like asthma, obesity, and inflammation.”
The research paper titled “A bitter anti-inflammatory drug binds at two distinct sites of a human bitter taste GPCR” is now available at Nature Communications and can be accessed at https:// www.nature.com/articles/s41467-024-54157-6

Introducing Annotatability—a powerful new framework to address a major challenge in biological research by examining how artificial neural networks learn to label genomic data. Genomic datasets often contain vast amounts of annotated samples, but many of these samples are annotated either incorrectly or ambiguously. Borrowing from recent advances in the fields of natural language processing and computer vision, the team used artificial neural networks (ANNs) in a non-conventional way: instead of merely using the ANNs to make predictions, the group inspected the difficulty with which they learned to label different biological samples. Somewhat similarly to assessing why students find some examples harder than others, the team then leveraged this unique source of information to identify mismatches in cell annotations, improve data interpretation, and uncover key cellular pathways linked to development and disease. Annotatability provides a more accurate method for analysing genomic data on single cells, offering significant potential for advancing biological research, and in the longer term, improving disease diagnosis and treatment.
A new study led by Jonathan Karin, Reshef Mintz, Dr. Barak Raveh and Dr. Mor Nitzan from Hebrew University, published in Nature
Computational Science, introduces a new framework for interpreting single-cell and spatial omics data by monitoring deep neural networks training dynamics. The research aims to address the inherent ambiguities in cell annotations and offers a novel approach for understanding complex biological data.
Single-cell and spatial omics data have transformed our ability to explore cellular diversity and cellular behaviours in health and disease. However, the interpretation of these high-dimensional datasets is challenging, primarily due to the difficulty of assigning discrete and accurate annotations, such as cell types or states, to heterogeneous cell populations. These annotations are often subjective, noisy, and incomplete, making it difficult to extract meaningful insights from the data.
The researchers developed a new framework, Annotatability, which helps identify mismatches in cell annotations and better characterises biological data structures. By monitoring the dynamics and difficulty of training a deep neural network over annotated data, Annotatability identifies areas where cell annotations are ambiguous or erroneous. The approach also highlights intermediate cell states and


the complex, continuous nature of cellular development.
As part of the study, the team introduced a signal-aware graph embedding method that enables more precise downstream analysis of biological signals. This technique captures cellular communities associated with target signals and facilitates the exploration of cellular heterogeneity, developmental pathways, and disease trajectories.
The study demonstrates the applicability of Annotatability across a range of single-cell RNA sequencing and spatial omics datasets. Notable findings include the identification of erroneous annotations, delineation of developmental and disease-related cell states, and better
characterisation of cellular heterogeneity. The results highlight the potential of this framework for unravelling complex cellular behaviours and advancing our understanding of both health and disease at the single-cell level.
The researchers’ work presents a significant step forward in genomic data interpretation, offering a powerful tool for unravelling cellular diversity and enhancing our ability to study the dynamics of health and disease.
The research paper titled “Interpreting single-cell and spatial omics data using deep neural network training dynamics” is now available in Nature Computational Science and can be accessed at https://www.nature.com/articles/s43588-024-00721-5
A study at the Hebrew University reveals how repeated fasting enhances the liver’s ability to adapt through a cellular memory mechanism. The research shows that alternate-day fasting “sensitises” key genes and liver enhancers, boosting ketogenesis during subsequent fasting bouts. This process, driven by the transcription factor PPARα, highlights how the body adjusts to recurring nutritional challenges. These findings provide fresh insights into the metabolic benefits of fasting and its potential applications in health and dietary science.
Fasting is an integral part of everyday life for millions of people worldwide, often practiced for religious or spiritual purposes. Observances such as Ramadan in Islam, Yom Kippur in Judaism, Lent in Christianity, and fasting rituals in Hinduism and Buddhism are deeply rooted in tradition and faith. These practices often involve repeated fasting periods, raising intriguing questions about how the body adapts to such recurring nutritional states.
In recent years, fasting has also become fashionable beyond its religious and cultural roots, embraced as a tool for improving health and promoting weight loss. Intermittent fasting, prolonged fasting, and time-restricted eating are


increasingly popular, with advocates claiming benefits such as enhanced metabolic health, weight management, and even longevity. This trend underscores the importance of understanding the physiological mechanisms underlying fasting, both in traditional contexts and as a modern lifestyle choice.
A new study published at Nucleic Acids Research led by Dr. Ido Goldstein from the Institute of Biochemistry, Food Science, and Nutrition at the Robert H. Smith Faculty of Agriculture, Food and Environment at the Hebrew University of Jerusalem reveals how repeated fasting triggers a cellular memory mechanism in the liver, enhancing its response to future fasting events. The research uncovers a fascinating link between alternate-day fasting (ADF) and the liver’s ability to adapt through heightened gene activation and production of a fuel termed ketone bodies, offering new insights into metabolic regulation.
Fasting induces metabolic changes in mammals, enabling the production of glucose and ketone bodies for energy during periods



of food scarcity. This process is driven by transcriptional changes in the liver (i.e. changes in the expression of genes). Dr. Goldstein’s team investigated how recurring fasting events, such as those experienced during ADF, influence this transcriptional program. Their findings revealed that mice undergoing ADF responded significantly differently to subsequent fasting bouts compared to mice fasting for the first time.
The study identified a phenomenon termed “sensitisation,” where key genes responsible for ketogenesis (the production of ketone bodies) were more strongly activated following ADF. This effect was linked to changes in the liver’s chromatin landscape, with enhancers—genomic regions that regulate gene expression—primed for stronger activation due to prior fasting experiences. These sensitised enhancers displayed increased binding of PPARα, a transcription factor critical for ketogenesis. Notably, this adaptive response was absent in hepatocyte-specific PPARα-deficient mice, highlighting PPARα’s essential role in this process.
The researchers found that the effects of ADF were evident after just one week of repeated fasting, leading to augmented production of ketone bodies during subsequent fasts. During feeding periods, gene expression and ketone
levels returned to baseline, demonstrating that the sensitisation effect is specific to fasting states. The health benefits of ADF, including improved lipid metabolism, appear to be linked to this enhanced ketogenic capacity rather than to changes in calorie intake or body mass, which remained largely unchanged.
Dr. Goldstein noted, “Our study highlights how the liver adapts to repeated fasting through a memory-like mechanism that prepares it for future fasting bouts. This enhancer sensitisation process underscores the liver’s remarkable ability to dynamically respond to recurring nutritional states.”
The findings provide a deeper understanding of how repeated environmental signals, such as fasting, shape cellular behaviour and metabolic adaptation. Beyond fasting, this research opens new avenues for exploring how transcriptional regulation mediates responses to other recurring environmental stimuli, with potential applications in dietary science and metabolic health.
The research paper titled “Repeated fasting events sensitise enhancers, transcription factor activity and gene expression to support augmented ketogenesis” is now available in Nucleic Acids Research and can be accessed at https://doi.org/10.1093/nar/gkae1161
The Israeli Phage Therapy Center (IPTC) of the Hebrew University and Hadassah have decided to name a newly discovered phage by Sigal Vorzhev in honour of her late life partner, Maj. Gen. Raz Abulafia, who fell in battle during the War of the Iron Swords. The centre, which focuses on using phages to combat antibiotic-resistant bacteria, has been naming newly discovered phages after fallen heroes from the conflict. Sigal, a researcher at the lab, named one phage “KpRaz1” in tribute to Raz, and if it proves effective in treating bacterial infections, it could potentially save lives. This tribute not only honours her partner’s sacrifice but also contributes to advancing medical research with the potential to impact patient care for years to come.
As part of her biotechnology studies at the Israeli Phage Centre of the Hebrew University and Hadassah, Sigal is combining her personal loss with cutting-edge scientific work which together with her partner Shira Meuchas-Heilbron aimed at fighting antibioticresistant bacteria. Sigal works under the guidance of Prof. Ronen Hazan and doctoral student Ortal Yerushalmy from the Faculty of Dentistry
The Israeli Phage Therapy Centre, is focused on the therapeutic potential of phages—viruses that target and kill bacteria with precision, offering a potential solution to the growing crisis of antibiotic resistance. So far, the centre has isolated and characterised hundreds of new phages, making strides toward innovative treatments.


KpRaz1 Phage, Electron Microscopy Unit, Interdepartmental Equipment, Ein Kerem Campus of the Hebrew University. Credit: Edi Bernstein
Each newly isolated phage at IPTC is assigned a name, often honouring individuals whom the researchers admire, such as historical figures like Janusz Korczak, respected scientists in the phage research field, or even family members of the team. In 2023, following the outbreak of the War of the Iron Swords, the lab decided to name newly discovered phages after fallen



soldiers and civilians as a tribute to their memory. Among those commemorated are Alon Shimriz, Yanai Kaminka, and Arnon Zmora.
Prof. Avraham Zini, Dean of the Faculty of Dental Medicine: “This initiative embodies the intersection of scientific innovation and deep personal tribute. Through Sigal’s and Shira’s work, we not only advance the fight against antibiotic-resistant bacteria but also ensure that the legacy of fallen heroes continues in a meaningful and life-saving way.”
Sigal Vorzhev said: “Naming this phage after Raz is my way of honouring his memory—not only as a soldier and a leader but as someone who dedicated his life to protecting others. If
KpRaz1 can one day help save lives, it will be a tribute worthy of him.”
This tribute to Raz is not just a symbol of remembrance; it may one day play a role in saving lives. If the KpRaz1 phage is found to match a patient’s bacterial infection, it could provide a life-saving treatment, continuing Raz Abulafia’s legacy of service in an entirely new and profound way.
and a Fields Medal. Ranked 81st globally by the Shanghai Ranking (2024), it celebrates a century of excellence in research, education, and innovation. To learn more about the university’s academic programs, research, and achievements, visit the official website at http://new.huji.ac.il/en.


Humpback whale song is a striking example of a complex, culturally transmitted behaviour, but up to now, there was little evidence it has language-like structure. Human language, which is also culturally transmitted, has recurring parts whose frequency of use follows a particular pattern. In humans, these properties help learning and may come about because they help language be passed from one generation to the next. This work innovatively applies methods inspired by how babies discover words in speech to humpback whale recordings, uncovering the same statistical structures found in all human languages. It reveals previously undetected structure in whale song, illustrating a deep commonality between two unrelated species united by the fact that their communication systems are culturally transmitted.
Language has long been considered a uniquely human trait, with features that mark it out as distinct from the communication of all other species. However, research published recently in Science has uncovered the same statistical structure that is a hallmark of human language in humpback whale song.
Humpback whale song is a striking example of a complex, culturally transmitted behaviour, but up to now, there was little evidence it has language-like structure. Human language, which is also culturally transmitted, has recurring parts whose frequency of use follows a particular pattern. In humans, these properties help learning and may come about because they help language be passed from one generation to the next. This work innovatively applies methods inspired by how babies discover words in speech to humpback whale recordings, uncovering the same statistical structures found in all human languages. This work reveals previously undetected structure in whale song, illustrating a deep commonality between two unrelated species united by the
fact that their communication systems are culturally transmitted.
Led by Professor Inbal Arnon of the Hebrew University, Dr Ellen Garland of the University of St Andrews, and Professor Simon Kirby of the University of Edinburgh, in collaboration with Dr Claire Garrigue (IRD New Caledonia), Dr Jenny Allen (Griffith University), and Dr Emma Carroll (University of Auckland), this work represents a unique collaboration between linguists, developmental scientists, marine biologists and behavioural ecologists.
Humpback whale song is one of the most striking examples of a socially learned, culturally transmitted behaviour in a nonhuman animal. Whale song exhibits systematic structure, however, until now, there was little evidence that this structure was like that of human language.
One of the big challenges in studying nonhuman communication is finding out what the relevant parts of the system are. The authors’ breakthrough was to use insights from how babies discover words in speech, and apply them to eight years of humpback whale song data collected in New Caledonia. The authors found that whale song showed the same key statistical properties present in all known human languages. They detected recurring parts whose frequency closely followed a particular skewed distribution, not previously found in any other non-human animal.
This work reveals a deeply unexpected commonality between two unrelated species - humans and humpback whales - united by the fact that their communication system is culturally transmitted. This points to the crucial role of learning and transmission in the emergence of structure within such systems. Once thought of as the hallmark of human uniqueness, foundational aspects of human language may be shared across evolutionary distant species.

Dr Ellen Garland from the University of St Andrews said: “Revealing this hidden language-like structure in whale song was unexpected, but it strongly suggests this cultural behaviour holds crucial insight into the evolution of complex communication across the animal kingdom.”
“Whale song is not a language; it lacks semantic meaning. It may be more reminiscent of human music, which also has this statistical structure, but lacks the expressive meaning found in language.”
“Whether the units we detected using the infant-inspired method are salient to the whales themselves remains an open question.”
Prof Inbal Arnon from the Hebrew University said: “Using insights and methods from how babies learn language allowed us to discover previously undetected structure in whale song
“This work shows how learning and cultural transmission can shape the structure of communication systems: we may find similar statistical structure wherever complex




sequential behaviour is transmitted culturally.”
“It raises the intriguing possibility that humpback whales, like human babies, may learn their song by tracking transitional probabilities between sound elements, and using dips in those probabilities as a cue to segment the song”
Prof Simon Kirby from the University of Edinburgh said:
“It suggests that our understanding of the evolution of language can benefit not only from looking at our closest primate relatives, but also at cases of convergent evolution elsewhere in nature.”
“Looking beyond the way language is used to express meaning, we should consider how language is learned and transmitted culturally over multiple generations.”
“These findings challenge long held assumptions about the uniqueness of human language, uncovering deep commonalities between evolutionarily distant species.”

The research paper titled “Whale song shows language-like statistical structure” is now available in Science and can be accessed at DOI: 10.1126/ science.adq7055

planting, particularly in tourist areas and regions with rare species. The Eucalyptus species showed large differences in their effect, thus, prioritising Eucalyptus species with minimal adverse effects is recommended for future reforestation efforts.
The study was conducted in the spring
findings will contribute to these restoration efforts.
The Western Negev region of Israel, characterised by its extensive Eucalyptus plantations, has been the subject of ongoing debate due to Eucalypti being an alien species. Eucalyptus is famous for allelopathy - the



chemical inhibition of one plant species by another - which can significantly impact local vegetation. This study, conducted in the Be’eri forest and near Kibbutz Re’im, focused on understanding these effects on herbaceous plant communities that are crucial for ecosystem services, such as grazing and cultural significance.
The new study by Yuval Neumann and Dr. Niv DeMalach from the Faculty of Agriculture, Food and Environment at the Hebrew University examined the impact of three Eucalyptus species: E. camaldulensis, E. loxophleba, and E. torquata. Key findings include:
Herbaceous Biomass Reduction Under the Eucalypti canopy a significant reduction in


herbaceous biomass was observed, even when controlling for shading.
Flowering Density of Red Anemones: A negative impact on the flowering density of red anemones (A. coronaria) was observed.
Ecosystem Services: Eucalypti provide numerous ecosystem service, such as s security-forestation (hiding settlements), as nectar providers, or shade providers. Their potential negative impact on ecosystem services is through reducing the flowering
density of red anemones, which in turn are an economical ecosystem service as they attract tourism.
Differences between the species: The study found major differences in the three Eucalyptus species’ effect on herbaceous communities, with E. torquata having a negative effect on biodiversity (of up to ~90% reduction), while the other two species did not show an effect.
Given the findings, the researchers advise caution in planting certain Eucalyptus species’


trees in areas intended for tourism, such as the ‘Darom Adom’ (red south) festival, and in regions home to rare or protected species. Significant differences between Eucalyptus species were noted, with some species exhibiting minor negative effects. Therefore, the researchers recommend prioritising species with minimal impact for reforestation efforts.
This study underscores the need for careful consideration of the ecological impacts of Eucalyptus plantations in the Western Negev. While these trees offer certain benefits, their
allelopathic properties can negatively influence local plant communities and ecosystem services. Reforestation efforts should be led by data-driven decision-making, and supported by further research, to deepen our understanding.
The research paper titled “The effects of Eucalyptus on herbaceous plant communities in the Western Negev” is now available in Hebrew at Ecology and Environment (ekologia ve seviva) and can be accessed at https://magazine.isees.org.il/?p=57779
Antibiotics are crucial in modern medicine, but their widespread use has led to antibiotic-resistant bacteria, posing a serious public health threat. A new study highlights the potential of random antimicrobial peptide mixtures to significantly reduce the risk of resistance evolution compared to single peptides. These findings support the development of new antimicrobial strategies, emphasising the need for innovative solutions to outpace bacterial resistance and safeguard public health.
Antibiotics are essential tools in modern medicine, regularly used to treat bacterial infections and prevent infections during surgery. However, the widespread use of antibiotics has led to many bacteria developing resistance, posing a significant threat to public health. A recent study published in PLOS Biology, led by Prof. Zvi Hayouka from the Institute of Biochemistry Food science and Nutrition at the Faculty of Agriculture, Food and Environment at the Hebrew University of Jerusalem, and Prof. Jens Rolff from the Freie Universität Berlin, along with postdoctoral fellow Dr. Bernardo Antunes, who was affiliated with both Hebrew University and Freie Universität Berlin, highlights the urgent need for new strategies to control bacterial infections due to the growing threat of antibiotic-resistant pathogens. Proper antibiotic use, quick diagnostics, and careful development of new antimicrobial agents, ideally less likely to select for resistance than current antibiotics, are crucial.
Antibiotic resistance is emerging as a pressing global health challenge. While individuals themselves do not become resistant to antibiotics, the bacteria causing infections can develop this resistance, leading to more difficultto-treat illnesses. Recent data from the World Health Organisation highlights the severity of this issue, with some countries reporting resistance rates as high as 42% for certain common bacterial strains. In the United States, the Centers for Disease Control and Prevention estimates that over 2 million antibiotic-resistant infections occur annually, underscoring the urgency of addressing this crisis.
The study explored whether newly developed random antimicrobial peptide mixtures can significantly reduce the risk of resistance evolution compared to single sequence antimicrobial peptides. The research team used the ESKAPE pathogen Pseudomonas aeruginosa, a model gram-negative bacterium, known for its challenging infections due to

inherent resistance to many drug classes and its ability to form biofilms.
Pseudomonas aeruginosa was experimentally evolved in the presence of antimicrobial peptides or random antimicrobial peptide mixtures to assess resistance evolution and cross-resistance between treatments. The study also examined the fitness costs of resistance on bacterial growth and used whole-genome sequencing to identify mutations responsible for resistance. Additionally, changes in the pharmacodynamics of the evolved bacterial strains were analysed.
The findings suggest that random antimicrobial peptide mixtures pose a much lower risk
of resistance evolution compared to single antimicrobial peptides and mostly prevent cross-resistance to other treatments while maintaining or improving drug sensitivity. Prof. Zvi Hayouka emphasised the significance of their work, stating, “The growing threat of antibiotic-resistant bacteria demands innovative solutions. Our research on random antimicrobial peptide mixtures presents a promising approach to outpace bacterial resistance, offering a viable alternative to traditional antibiotics and safeguarding public health.”
This research suggests that Pseudomonas aeruginosa can detect these antimicrobial agents but cannot develop effective resistance within 4 weeks in vitro. Additionally, these

Australia
T: +61 3 9525 3777
F: +61 3 9537 1104 lowelippmann.com.au

Partners
Joseph
Danny
Gideon
Loren
Michael
Joseph
Daniel
Richard
antimicrobial peptide cocktails are affordable to synthesise and have proven to be non-toxic and non-hemolytic in a mouse model with strong efficacy profiles in several mouse model of human pathogenic bacterial infection model.
The findings advocate for the use of random antimicrobial peptide cocktails over single peptides, as resistance developed in vitro against single peptides. Despite some antibiotics, like Teixobactin, initially being deemed “resistance-proof,” this was later disproven, necessitating caution even with the promising results for the random peptide mixture. Further research should explore the interaction of these random peptide mixtures with the host immune system. Employing peptides that synergise with the host response could diminish dosage requirements and side effects. This approach could be a cost-effective method to reduce bacterial loads and prevent resistance.
“It will still be quite some time before we are ready for practical applications,” says Prof. Jens Rolff. “Still, our current work demonstrates the potential that these combinations have when it comes to reducing antimicrobial resistance.”
Alongside their active research, Prof. Zvi Hayouka has co-founded a company, in partnership with Hebrew University’s technology transfer company, Yissum, dedicated to addressing antibiotic resistance through innovative solutions Pepticore (https://

tarominnovative.com/projects/pepticore/). The company aims to develop and commercialise new antimicrobial agents less likely to select for resistance. Their approach includes using different combinations of antibiotics and exploring mixtures made up of millions of molecules to inhibit resistance. This initiative is crucial, as antibiotic-resistant pathogens are estimated to cause approximately 5 million deaths annually. Despite advances in diagnostics and prudent antibiotic prescribing, developing new drugs remains essential to combat increasingly resistant bacteria.
The research paper titled “The evolution of antimicrobial peptide resistance in Pseudomonas aeruginosa is severely constrained by random peptide mixtures” is now available in PLOS Biology and can be accessed at https://doi.org/10.1371/ journal.pbio.3002692
Yissum is the technology transfer company of the Hebrew University of Jerusalem. Founded in 1964, Yissum serves as a bridge between cutting-edge academic research and a global community of entrepreneurs, investors, and industry. Yissum’s mission is to benefit society by converting extraordinary innovations and transformational technologies into commercial solutions that address our most urgent global challenges. The company has registered more than 11,680 patents globally, licensed over 1,160 technologies, and has spun out over 260 companies. Yissum’s business partners span the globe. For further information please visit www.yissum.co.il

A new study demonstrates an advance in treating antibioticresistant infections in animals through personalized phage therapy. The treatment combined a specific anti-P. aeruginosa phage applied topically with ceftazidime administered intramuscularly, resulting in the complete healing of a persistent surgical wound after fourteen weeks. This highlights the potential of phage therapy as a practical and effective solution for antibiotic-resistant infections in veterinary practice, with implications for human medicine as well.
The study led by Prof. Ronen Hazan and his team, from the Faculty of Dental Medicine at the Hebrew University of Jerusalem, in collaboration with the team of Vet Holim, JVMV -Veterinary medical center in Kiryat -Anavim, Israel, has shown an advance in the treatment of antibiotic-resistant infections in animals. This research, focusing on a five-year-old Siamese cat Squeaks with a multidrug-resistant Pseudomonas aeruginosa infection postarthrodesis surgery, marks the first published documented application of personalised phage therapy in veterinary medicine.
Squeaks, initially treated at the JVMV for injuries sustained from a high-rise fall,
developed a severe infection in the right hind leg following multiple surgeries. This infection persisted despite various antibiotic treatments over four months. Facing a potential implantreplacement surgery, the team turned new treatment which involved a meticulously designed combination of a specific anti-P. aeruginosa phage, a virus that kills bacteria, applied topically to the surgical wound and ceftazidime administered intramuscularly. Moreover, the owners of the cat, after short demonstration, provides most of the treatment doses of phages and antibiotics at their home.
The integration of phage therapy with antibiotics was aimed at targeting the pathogen effectively



and directly at the site of infection, leveraging the phage’s ability to be applied topically, which simplifies administration and maximises its concentration at the infection site. This approach allowed the surgical wound, which had remained open for five months, to fully heal after fourteen weeks of treatment.
The successful outcome of this case underscores the critical need for novel therapeutics like phage therapy to address the growing concern of antibiotic-resistant infections, which affect up to 8.5% of surgical sites following orthopedic surgeries in companion animals. These infections not only pose significant health risks to the animals but
also increase the morbidity, mortality, and costs associated with these procedures.
Recent studies suggest that phage therapy, already showing high success rates in human medicine for treating orthopedic infections and chronically infected wounds, can offer a promising solution for similar issues in veterinary practice. Moreover, the successful treatment of this cat by its owners at home highlights the practicality and efficacy of personalised phage therapy, which could be extended to treat other pets facing similar antimicrobial resistance challenges.
Interestingly, opposite to common situations, this






case was performed on an animal based on the team’s insights from treating humans first.
The positive reception from veterinarians and pet owners regarding phage therapy points to a growing awareness and acceptance of this treatment option. As the new treatment continues to be explored in veterinary settings, it not only improves the health and well-being of pets but also offers valuable data that contribute to the broader application of phage therapy in both animals and humans. This bridging
of data can enhance treatment protocols and outcomes across a variety of bacterial infections, potentially changing the landscape of infection treatment in both veterinary and human medicine.
The research paper titled “Successful phage-antibiotic therapy of P. aeruginosa implant-associated infection in a Siamese cat” is now available in Veterinary Quarterly and can be accessed at https://doi.org/10.1 080/01652176.2024.2350661.



Scholars from the Austrian Academy of Sciences, the University of Vienna and the Hebrew University of Jerusalem have unveiled a unique papyrus from the collections held by the Israel Antiquities Authority, offering rare insights into Roman legal proceedings and life in the Roman Near East. In a new publication in the international scholarly journal Tyche, the research team reveals how the Roman imperial state dealt with financial crimes – specifically, tax fraud involving slaves – in the Roman provinces of Iudaea and Arabia. The new papyrus furnishes a strikingly direct view of Roman jurisdiction and legal practice, as well as important new information about a turbulent era shaken by two massive Jewish revolts against Roman rule.
The longest Greek papyrus ever found in the Judaean Desert, comprising over 133 lines of text, has now been released for the first time. Initially misclassified as Nabataean, the papyrus remained unnoticed for decades until its rediscovery in 2014 by Prof. Hannah Cotton Paltiel, emerita of the Hebrew University. “I volunteered to organise documentary papyri in the Israel Antiquities Authority’s scrolls laboratory, and when I saw it, marked ‘Nabataean,’ I exclaimed, ‘It’s Greek to me!’” recalls Prof. Cotton Paltiel. In recognition of her discovery, the papyrus has been named P. Cotton, in line with papyrological conventions.
Recognising the document’s extraordinary length, complex style, and potential ties to Roman legal proceedings, Prof. Cotton Paltiel assembled an international team to decipher it. The team, including Dr. Anna Dolganov of
the Austrian Academy of Sciences, Prof. Fritz Mitthof of the University of Vienna and Dr. Avner Ecker of Hebrew University, determined the document to be prosecutors’ notes for a trial before Roman officials on the eve of the Bar Kokhba revolt (132–136 CE), including a rapidly drafted transcript of the judicial hearing itself. The language is vibrant and direct, with one prosecutor advising another on the strength of various pieces of evidence and strategising to anticipate objections. “This papyrus is extraordinary because it provides direct insight into trial preparations in this part of the Roman Empire,” says Dr. Dolganov. Dr. Ecker adds, “This is the best-documented Roman court case from Iudaea apart from the trial of Jesus.”
The papyrus details a gripping case involving forgery, tax evasion, and the fraudulent sale



and release of slaves in the Roman provinces of Iudaea and Arabia, roughly corresponding to modern Israel and Jordan. The main defendants, Gadalias and Saulos, stand accused of corrupt dealings. Gadalias, the son of a notary and possibly a Roman citizen, had a criminal history involving violence, extortion, counterfeiting, and inciting rebellion. Saulos, his collaborator, orchestrated the fictitious sale and manumission of slaves without paying the requisite Roman taxes. To conceal their activities, the defendants forged documents. “Forgery and tax fraud carried severe penalties under Roman law, including hard labor or even capital punishment,” explains Dr. Dolganov.
This criminal case unfolded between two major Jewish uprisings against Roman rule: the Jewish Diaspora revolt (115–117 CE) and the Bar Kokhba revolt (132–136 CE). Notably, the text implicates Gadalias and Saulos in rebellious activities during Emperor Hadrian’s visit to the region (129/130 CE) and names Tineius Rufus, the governor of Iudaea when the Bar Kokhba revolt began. In the wake of prior unrest, Roman authorities likely viewed the defendants with suspicion, connecting their crimes to broader conspiracies against the empire. “Whether they were indeed involved in rebellion remains an open question, but the insinuation speaks to the charged atmosphere


of the time,” notes Dr. Dolganov. As Dr. Ecker points out, the nature of the crime raises questions, as “freeing slaves does not appear to be a profitable business model.” The enslaved individuals’ origins remain unclear, but the case may have involved illicit human trafficking or the Jewish biblical duty to redeem enslaved Jews.
The papyrus offers new insights into Roman law in the Greek-speaking eastern empire, referencing the governor of Iudaea’s assize tour and compulsory jury service. “This document shows that core Roman institutions documented in Egypt were also implemented throughout the empire,” notes Prof. Mitthof. The papyrus also
showcases the Roman state’s ability to regulate private transactions even in remote regions. Likely originating from a hideout cave in the Judaean Desert during the Bar Kokhba revolt, its careful preservation remains a mystery, and the trial’s outcome may have been interrupted by the rebellion
The research paper titled “Forgery and Fiscal Fraud in Iudaea and Arabia on the Eve of the Bar Kokhba Revolt: Memorandum and Minutes of a Trial before a Roman Official (P.Cotton)” is now available in Tyche and can be accessed at https://tyche.univie.ac.at/ index.php/tyche/article/view/9224
The study sheds light on the profound challenges faced by mothers of young children in maintaining health-promoting activities (HPA) following man-made disasters, including terrorist attacks. Conducted by Shahar Zaguri-Vittenberg, Anat Golos, and Jennifer Budman from School of Occupational Therapy in the Hebrew University, the research provides critical insights into the experiences of Israeli mothers in the aftermath of the October 7, 2023, terrorist attacks.
The study, published in Psychological Trauma: Theory, Research, Practice, and Policy, reveals a significant decline in maternal participation in HPAs—activities that support physical, emotional, and social well-being—in the wake of the attacks. The findings emphasise the importance of social support in mitigating the negative impacts of disaster exposure, offering valuable guidance for disaster response and community health planning.
Key Findings:
Decreased Participation in Health-Promoting Activities: Most surveyed mothers reported reduced frequency and perceived competence in engaging in HPAs post-disaster, with disaster exposure strongly correlating to these declines.
Social Support as a Protective Factor:
Social support moderated the effect of disaster exposure, helping mothers maintain a sense of competence in their participation.
Barriers and Enablers:
Through qualitative analysis, four key themes
emerged: Consequences of Disaster Exposure: Emotional, cognitive, social, physical, and institutional factors that hinder participation.
External Resources:
Availability of social, community and institutional support.
Life-Role Overload:
Competing demands from caregiving and other responsibilities.
Adaptive Thinking:
Strategies mothers employed to cope and prioritise self-care, while aligning with their values and fostering feelings of selfcompassion, acceptance, and gratitude.
Clinical and Policy Implications:
The research underscores the vulnerabilities of mothers as primary caregivers during crises. “Disasters place enormous physical and emotional burdens on mothers of young children, limiting their ability to care for
themselves,” the authors explained. “Our findings highlight the need for targeted interventions that prioritise maternal health and well-being while strengthening social support systems.”
These findings have important implications for policymakers and health professionals, urging them to:
• Develop community-based support networks that address the unique challenges mothers face post-disaster.
• Implement early intervention programs aimed at enhancing maternal resilience and promoting HPAs.
• Allocate resources to ensure equitable access to mental health and social services for families in disaster-affected areas.
This study marks an essential step toward understanding how man-made disasters impact maternal health and participation in daily activities. As disasters continue to rise globally, these insights are critical for fostering resilience and community wellbeing.
The research involved 201 Israeli mothers of children aged 0-12, who completed an online survey within a month of the October 2023 terror attacks. The survey
captured data on disaster exposure, maternal participation in HPAs, and social support, as well as qualitative insights into factors enabling or hindering participation.
The research paper titled “Participation in Health-Promoting Activities of Mothers of Young Children Post-Man-Made Disaster Caused by Terrorist Attack” is now available in Psychological Trauma: Theory, Research, Practice, and Policy and can be accessed at https://psycnet.apa.org/ fulltext/2025-42100-001.html https://dx.doi.org/10.1037/tra0001824




DIRECTORS:


A new study has uncovered a surprising link between Alzheimer’s disease and Herpes Simplex Virus-1 (HSV-1). Researchers found HSV-1 proteins embedded in Alzheimer’s brains, revealing how the virus is inhibited by tau protein—a key player in the disease. These insights could pave the way for innovative treatments targeting viral activity and the brain’s immune response to slow or even stop Alzheimer’s progression.
Led by Dr. Or Shemesh from the School of Pharmacy at the Hebrew University of Jerusalem the study has uncovered a surprising connection between Alzheimer’s disease and the Herpes Simplex Virus-1 (HSV-1). The research team used advanced techniques to identify 19 HSV-1-related proteins in the brains of people with Alzheimer’s, across all stages of the disease. This discovery
strengthens the growing evidence that infections like HSV-1 might play a role in the development and progression of Alzheimer’s.
One key finding was the increased activity of a herpesvirus protein called ICP27, which became more prominent as the disease advanced. This protein was found to occupy the same space as tau, a brain protein that becomes harmful when it undergoes changes in Alzheimer’s disease, but it did not appear near amyloid plaques, another hallmark of the illness. This suggests that HSV-1 may directly affect tau and contribute to the changes seen in Alzheimer’s.
The team’s experiments with human brain organoids derived from stem cells revealed that HSV-1 infection can increase tau modifications at specific sites linked to Alzheimer’s disease.

Tel: (03) 8564 1222

damage associated with Alzheimer’s. The study also highlighted the role of Alzheimer’s pathologies as part of the brain’s natural immune system in this process, focusing on a pathway called cGAS-STING, which influences tau changes.
Dr. Shemesh explained, “Our research shows how HSV-1 interacts with the brain and influences the pathologies of Alzheimer’s disease. Early on, the changes in tau may protect brain cells by limiting the virus, but as the disease advances, these same changes could lead to more harm and accelerate
suggests that targeting viral activity or modifying the immune system’s response could offer new treatment possibilities. While more research is needed to fully understand these processes, these findings open the door to innovative ways to slow or stop the progression of this devastating disease.
The research paper titled “Anti-Herpetic Tau Preserves Neurons vis the cGAS-STING-TBK1
Pathway in Alzheimer’s Disease” is now available in Cell Reports and can be accessed at https://www. cell.com/cell-reports/fulltext/S2211-1247(24)01460-8 (DOI: 10.1016/j.celrep.2024.115109)

A new study at Hebrew University explored the balance between AI and human therapists in mental health therapy, focusing on the role of empathy. The researchers propose a hybrid model where AI supports therapeutic processes without replacing the crucial human elements of empathy and emotional engagement. The study calls for further investigation into how AI can enhance therapy while ensuring genuine human connections are maintained.
The study by researchers from the Psychology Department at the Hebrew University published in JMIR Ment Health have made significant strides in understanding the role of artificial intelligence (AI) in mental health therapy. Their research focuses on the delicate balance between AI-driven interactions and the irreplaceable human touch in therapeutic settings, addressing critical questions about when AI might effectively replace human therapists and when the human connection remains indispensable.
Led by Prof. Anat Perry, the team has carefully defined various aspects of empathy, comparing the empathic capabilities of humans and AI. In the current JMIR paper, the authors delve into how AI versus human capabilities align with the therapeutic needs, considering both the methodologies employed in therapeutic settings and the individual goals of patients. The study emphasises the nuanced role of empathy in

therapy, underscoring that while AI can simulate empathic interactions and sometimes even create the impression of understanding beyond human capabilities, it lacks the ability to genuinely connect on an emotional level, and crucially to genuinely care.
Prof. Perry highlights the core of their findings, stating, “While AI can provide responses that seem empathically correct, true empathy involves an emotional engagement, and signalling of genuine care, that AI simply does not have. Our study seeks to explore this boundary to better understand when AI can be beneficial in therapy and when it cannot.”
The research proposes a novel hybrid therapeutic model where AI supports but does not replace human therapists. This model suggests that AI could effectively handle tasks such as initial patient intake and routine evaluations, and even assist in certain treatment

modalities. However, it crucially maintains that human therapists should be involved in situations where deep empathy and compassion are required, ensuring that the therapy remains grounded in genuine human interaction.
This study aligns with emerging trends in the field of mental health therapy, where technology is increasingly integrated into traditional therapeutic practices. Existing models, such as those combining cognitivebehavioral therapy (CBT) with AI-driven tools, have shown promise in enhancing accessibility and efficiency of therapy. For instance, AI applications can offer real-time feedback and personalised recommendations, complementing the therapist’s role and enabling more effective treatment plans.
Though much of the research remains theoretical, it raises empirical questions that are vital for the future of mental health therapy. The team calls on both industry professionals developing AI applications for mental health and academic researchers to consider these insights


and the importance of maintaining human elements in therapy.
These theoretical opinion papers serve as a crucial reminder of the need to carefully evaluate the use of AI in mental health therapies, balancing technological innovations with the essential human connections that form the backbone of effective therapeutic relationships.
This is Perry’s third paper on the topic, following an influential Correspondence piece in Nature Human Behaviour last year (https://www.nature.com/articles/ s41562-023-01675-w), and a Correspondence on AI, empathy and ethics published with a team of interdisciplinary scholars last month in Nature Machine Intelligence (https://www.nature.com/ articles/s42256-024-00841-7).
The research paper titled “Considering the Role of Human Empathy in AI-Driven Therapy” is now available in JMIR Ment Health and can be accessed at https://doi.org/10.2196/56529

Researchers at the Hebrew University have successfully used gene-editing technology to enhance the nutritional value of lettuce. The study demonstrates a significant increase in β -carotene (provitamin A), zeaxanthin, and ascorbic acid (vitamin C) without compromising plant growth or yield. This breakthrough highlights the potential of gene editing to combat micronutrient deficiencies and improve the dietary quality of widely consumed crops.


The research team led by Prof. Alexander Vainstein from the Robert H. Smith Faculty of Agriculture, Food, and Environment at The Hebrew University of Jerusalem has developed a new variety of lettuce with significantly higher levels of essential vitamins and antioxidants. Their findings, published in Plant Biotechnology Journal, demonstrate how CRISPR geneediting technology can enhance the nutritional content of lettuce by increasing the amounts of β-carotene (provitamin A), zeaxanthin, and ascorbic acid (vitamin C), making it a more nutrient-rich food option. This achievement was made possible by combining modifications in different biochemical pathways, allowing the researchers to enhance multiple nutritional values simultaneously rather than targeting a single nutrient.
CRISPR, short for Clustered Regularly Interspaced Short Palindromic Repeats, is a powerful and precise tool for editing DNA. Unlike traditional genetic modification (GMO) methods, which introduce foreign DNA, CRISPR allows scientists to make targeted changes within a plant’s own genetic code. This technology enables researchers to enhance crop traits such as nutritional content, disease resistance, and environmental adaptability more efficiently than ever before.
By modifying key genes that regulate vitamin and antioxidant production, the researchers were able to increase β-carotene levels by 2.7 times, improving its role as a precursor to vitamin A, which is essential for vision, immune function, and skin health. Zeaxanthin,



an important antioxidant that helps protect the eyes from blue light damage and age-related macular degeneration, was boosted to levels not typically found in lettuce. The researchers also achieved a 6.9-fold increase in ascorbic acid, commonly known as vitamin C, which strengthens the immune system and enhances iron absorption.
Despite these genetic modifications, the lettuce retained its normal growth, appearance, and yield, demonstrating that its improved nutritional profile does not come at the expense of its agricultural performance. “Gene editing provides us with an unprecedented ability to improve the nutritional quality of crops without altering their growth or yield,” said Prof. Vainstein. “This study is an important
step toward developing healthier food options that can help address widespread nutrient deficiencies in modern diets.”
This breakthrough represents a significant step in the fight against micronutrient deficiencies, often referred to as “hidden hunger,” which affect millions of people worldwide. By applying cutting-edge gene-editing techniques, scientists are developing ways to improve the nutritional quality of everyday foods, making healthier diets more accessible.
The research paper titled “Combined enhancement of ascorbic acid, β-carotene and zeaxanthin in gene-edited lettuce” is now available in Plant Biotechnology Journal and can be accessed at https://onlinelibrary.wiley.com/ doi/10.1111/pbi.70018
New study explores the use of Random Antimicrobial Peptide Mixtures (RPMs) as a safe and effective alternative to antibiotics in cultured meat production. These synthetic peptide cocktails successfully eliminate bacterial contamination without harming stem cell viability or contributing to antibiotic resistance. The findings highlight RPMs as a promising solution for improving food safety and sustainability in cellular agriculture.
The study, led by researchers from The Hebrew University of Jerusalem, in collaboration with the Singapore-HUJ Alliance for Research and Enterprise (SHARE), has identified a promising non-antibiotic antimicrobial agent that could support cultured meat production. The study, conducted by Idan Yakir a PhD student and Prof. Zvi Hayouka, explores the use of Random Antimicrobial Peptide Mixtures (RPMs) as a safe and effective alternative to traditional antibiotics in cell culture environments.
Antibiotics are commonly used in cellbased meat production to prevent bacterial contamination. However, their use raises concerns about antibiotic resistance and residual traces in the final food products, which could impact public health and regulatory approval. The research team investigated the potential of RPMs—synthetic peptide cocktails with broad antimicrobial activity—as an innovative, antibiotic-free solution to protect

cultured meat cells from contamination.
RPMs demonstrated strong bactericidal activity against Gram-positive bacteria such as Listeria monocytogenes and Gram-negative bacteria E. coli without harming the host cells.
Mesenchymal stem cells (MSCs), crucial for cultured meat production, showed no significant toxicity when exposed to RPMs at concentrations effective against bacteria. Unlike conventional antibiotics, RPMs exhibited a low occurrence of bacterial resistance, making them a more sustainable and long-term alternative. The RPM mixture was quickly broken down in a simulated digestion model, indicating no risk of bioaccumulation or adverse health effects upon consumption.
The study marks a significant step toward scaling up cultured meat production while ensuring food safety and public health. Cultured meat



has been heralded as a sustainable alternative to traditional livestock farming, reducing environmental impact and minimising zoonotic disease risks. However, microbial contamination remains a key challenge. The findings suggest that RPMs could serve as a scalable, costeffective, and safe antimicrobial strategy in the growing field of cellular agriculture.
This research was supported by the SingaporeHUJ Alliance for Research and Enterprise (SHARE) under the Cellular Agriculture (CellAg) Programme at the Campus for Research Excellence and Technological Enterprise (CREATE) in Singapore. The partnership between The Hebrew University of Jerusalem and Singaporean research institutions plays a crucial role in advancing cutting-edge food technology solutions to address global food security challenges.
“Our findings demonstrate the immense
potential of RPMs as a novel class of antimicrobial agents for cultured meat production,” said Prof. Zvi Hayouka, the lead researcher on the project. “By eliminating the need for antibiotics in cellular agriculture, we can enhance consumer safety, regulatory compliance, and environmental sustainability.”
The team is now exploring industrial applications and regulatory pathways to integrate RPMs into commercial cultured meat production, aiming for broader adoption in the alternative protein industry and have established a startup company based on this technology termed Prevera https://prevera.co/
The research paper titled “Random antimicrobial peptide mixtures as non-antibiotic antimicrobial agents for cultured meat industry” is now available in Food Chemistry: Molecular Sciences and can be accessed at https://doi.org/10.1016/j. fochms.2025.100240.
The Hebrew University is launching a new master’s program focused on green energy technology, aimed at training future research leaders and fostering innovation in renewable energy. This initiative is expected to significantly advance Israel’s green energy sector, contribute to global efforts against climate change, and pave the way for a sustainable future.
In response to the critical global challenge of climate change, the master’s degree program in the next academic year is dedicated to developing new technologies for non-polluting energy sources. This unique curriculum aims to equip research students with the skills and knowledge needed to drive advancements in green energy.
The climate crisis is a pressing issue worldwide, and Israel is no exception. The discourse on renewable energy development and utilisation is gaining significant momentum in the country. By 2030, Israel aims for 30% of its energy production to come from renewable sources. In 2022, the government allocated 100 million NIS to support green energy projects, and in 2023, about 12.5% of national electricity consumption was derived from renewable sources.

The new master’s program at Hebrew University will address various aspects of green energy, including the development of ecofriendly materials, understanding application


mechanisms, creating green energy production devices, and tackling challenges in energy storage and management. This comprehensive approach will be complemented by direct collaboration with local and global industries.
Prof. Lioz Etgar, Head of Chemistry Studies, stated: “Our goal is to train the next generation of research leaders in the renewable energy industry. We will leverage the expertise of our distinguished faculty members, who are renowned experts in fields such as chemistry, materials science, nanotechnology, engineering, physics, biology, agriculture, economics, and social sciences. Through our collective knowledge and unique expertise,
we aim to foster groundbreaking research and development in Israel and beyond.”
The Hebrew University anticipates that training researchers in these critical areas will spur the growth of the green energy sector in Israel, leading to the creation of innovative start-ups and significant technological breakthroughs. Expected advancements include enhanced solar energy production, new approaches to solar fuels, the development of green hydrogen, and innovative energy storage solutions. These developments will contribute to mitigating global warming and ensuring a greener, more sustainable future for generations to come.






Andreasens Green is part of Australia’s largest wholesale supplier of plants to the landscape indus try. It has supplied many iconic developments over the l ast 40 years including Barangaroo Headland Park. The Green Family is proud to continue to support The Australian Friends of The Hebrew University. try.
https://andreasensgreen.com.au

Researchers at the Hebrew University enhanced the Elixhauser Comorbidity Model, improving predictions for length of hospital stay, mortality, readmission, and escalated care. The study outperformed the standard Elixhauser model, offering a comprehensive view of patient complexity. These findings benefit healthcare decisions and patient outcomes, with broad implications for the field.
Risk adjustment models play a critical role in guiding clinical care, adjusting case mix in research, and supporting health services planning and financing, including payment adjustments based on patient complexity. However, these models, such as the Elixhauser Comorbidity Measure, often focus solely on comorbid illnesses and may not fully capture a patient’s medical complexity. This is especially pertinent in Israel, where hospitals are reimbursed a fixed fee per day, irrespective of patient complexity.
Researchers at The Hebrew University have enhanced and externally validated the Elixhauser Comorbidity Model to improve its accuracy. The lead author was Dr. Gidon Liebner, a resident in orthopaedics at Hadassah hospital and a graduate of the Hebrew University School of Medicine. The senior authors are Drs. Shuli BrammliGreenberg and Adam Rose, professors at the Hebrew University School of Public Health.
The study, published in BMC Health Services Research, incorporated additional clinical and demographic data into the Elixhauser model. By incorporating additional clinical and demographic data, the study has improved the model’s accuracy in predicting key outcomes such as length of stay, in-hospital mortality, readmission within 30 days, and escalated care, meaning the intensive care unit or similar sorts of care.
This improved model not only aids healthcare professionals in making more informed clinical decisions but also enables more efficient resource allocation within healthcare facilities. The refined model enhances the overall quality of patient care, potentially leading to cost savings and contributing to advancements in healthcare research.
Leveraging Israel’s unique centralised health data repository, the study conducted a retrospective observational cohort analysis of

55,946 admissions to the internal medicine service of the Shaare Zedek Medical Center (Jerusalem). It found that the enhanced model outperformed the standard Elixhauser Model. By including variables such as laboratory test results, vital signs, and demographic information, the new model achieved significant improvements in prediction accuracy over the basic Elixhauser model, which has itself been in use for decades for this purpose.
The study showed that the upgraded model was better in predicting certain health outcomes. For example, when it came to estimating how long someone would stay in the hospital, the improved model increased its predictiveness from an R2 of 10.1% to 28.1%. Additionally, in predicting whether someone might pass away during their hospital stay, the model’s c-statistic, a measure of model predictiveness, went up from 71.1% to 87.9%. These improvements show that the enhanced model is better at figuring out and predicting
how long someone will be in the hospital and the risk of in-hospital mortality compared to the standard model.
“Our enhanced model fills a crucial gap in the original Elixhauser Model by providing a more comprehensive assessment of patient complexity,” said Prof. Adam J. Rose. “This model has broad applicability to other healthcare settings, both within and beyond internal medicine, and could support decisions regarding admission and care settings, home hospitalisation suitability, and payment adjustments based on patient complexity.”
The research paper titled “Incorporating Clinical and Demographic Data into the Elixhauser Comorbidity Model: Validation and Impact on Outcome Predictions in a Tertiary Hospital’s Internal Medicine Department” is now available in BMC Health Services Research and can be accessed at https:// rdcu.be/d2umv
A recent study at the Hebrew University reveals that a person’s name may influence their facial appearance over time. Using human perception tests and machine learning, the research found that adults’ faces can be matched to their names more accurately than chance. However, this effect is not found in children’s faces, suggesting that face-name congruence develops as individuals age rather than being present from birth. This “self-fulfilling prophecy” highlights how social expectations can subtly shape physical appearance. The findings have implications for psychology, sociology, and artificial intelligence, demonstrating the interaction between social factors and identity formation.
The debate about the meaning of stereotypes is longstanding. Do they carry an inherent, hereditary factor, where, for example, boys and girls differ biologically, or is it the influence of social expectations? While the effects of heredity are relatively straightforward to measure, isolating and empirically measuring the impact of the environment is much more challenging. The study led by Prof. Ruth Mayo at the Hebrew University, together with Dr. Yonat Zwebner, Dr. Moses Miller, Prof. Jacob Goldenberg of Reichman University’s Arison School of Business, and Noa Grobgeld from the Hebrew University, has made a groundbreaking achievement by demonstrating the significant impact of social structuring. It was found that this influence is so powerful that it can even change a person’s facial appearance.
The study has uncovered intriguing evidence that a person’s name may influence their facial appearance as they age. This research, which combines human perception tests and advanced machine learning techniques, offers new insights into the complex interplay between social expectations and self-identity development.
Building on previous findings that adults’ faces can be matched to their names at abovechance levels, Prof. Mayo’s team sought to determine whether this face-name congruence is present from birth or develops over time.
Key findings include:
• Both adults and children could accurately match adult faces to their names above chance levels.
• Neither adults nor children could match children’s faces to their names above chance levels.
• Machine learning algorithms found greater similarity between facial representations of adults sharing the same name compared to those with different names.
• This name-based facial similarity was not observed among children.
• Artificially aged images of children’s faces did not exhibit the face-name matching effect seen in actual adult faces.


“These results suggest that the congruence between facial appearance and names is not innate, but rather develops as individuals mature,” explains Prof. Mayo. “It appears that people may alter their appearance over time to conform to cultural expectations associated with their name.”
This “self-fulfilling prophecy” highlights the profound impact that social factors have. The study suggests that even seemingly arbitrary social tags like names can shape our appearance in subtle yet measurable ways.
The research raises fascinating questions about
identity formation and the long-term effects of social expectations on individual development.
Prof. Mayo emphasises that further research is needed to fully understand the mechanisms behind this face-name matching effect and its broader implications. However, this study represents a significant step forward in understanding how social factors shape who we become.
The research paper titled “Can names shape facial appearance” is now available in PNAS and can be accessed at https://doi.org/10.1073/pnas.2405334121





Your bequest or tax deductible gift in your lifetime will ensure that The Hebrew University continues its ground breaking programs, discoveries and innovation as Israel’s premier university and one of the top universities in the world.
“...support of The Hebrew University in Jerusalem and the maintenance of its high standards are of a decisive importance.”
Albert Einstein
- a founding father of The Hebrew University
For a confidential discussion on how your support can make a difference, contact CEO Robert Schneider, on (02) 9389 2825 or ceo@austfhu.org.au www.austfhu.org.au Can you improve on Einstein’s
ARGENTINA
T +54 11 4374 7045 info@huji.org.ar www.huji.org.ar
AUSTRALIA
T +61 2 9389 2825 austfhu@austfhu.org.au www.austfhu.org.au
AUSTRIA
T +43 1 5022 0188 Marcel.landesmann@ gutmann.at
BELGIUM
T +32 2 343 5546 contact@uhjerusalem.be www.befhu.org
BRAZIL
T +55 11 972 426 695 amigosbrasiluhj@gmail.
CANADA
T +1 416 485 8000 Toll Free 1-888-HEBREWU info@cfhu.org
CHILE
FRANCE
T +33 4250 4323 contact@uhjerusalem.org www.uhjfrance.org
GERMANY
T +030 8146 6230 info@fhuji.org www.fhuj.org
ISRAEL
T +972 2 588 2840 israelfriends@savion.huji.ac.il http://alumni.huji.ac.il/ http://shocharim.huji.ac.il/
ITALY
Milan Office
T +39 02 7602 3369 aug.it@tiscalinet.it
Rome Office
info@brainforum.it http://www.braincircleitalia.it
JAPAN
T +81 75 461 4603 tsujita@h2.hum.huji.ac.il
LUXEMBOURG
T +352 2 402 545 alainm@pt.lu
PANAMA ibtesh@rejovot.com
PERU amigos.uhj.pe@gmail.com
SOUTH AFRICA
T +27 82 551 2126 safhu@beyachad.co.za www.safhu.co.za
SWEDEN
T +46 496 570 846 petergoldmanoffice@gmail. com
SWITZERLAND
Zurich
T +41 61 262 04 47 hujschweiz@gmail.com www.huj-swissfriends.ch
Geneva
T +41 22 732 25 67 geneva@uhjerusalem.org www.uhjerusalem.ch

T +56 2 955 5067 simar.univhebrea. chile@gmail.com
EUROPE
T +972 2588 2809 eurodesk@savion.huji. ac.il
MEXICO
info@amauhj.org.mx www.amauhj.org.mx
THE NETHERLANDS
T +31 6 1444 2351 info@nvhu.nl www.nvhu.nl
UNITED KINGDOM & IRELAND
T +44 208349 5757 friends@bfhu.org www.bfhu.org
UNITED STATES
T +1 212 607 8500 info@afhu.org www.afhu.org
URUGUAY
T +598 2 712 3523 amigos.huji.uy@gmail.com